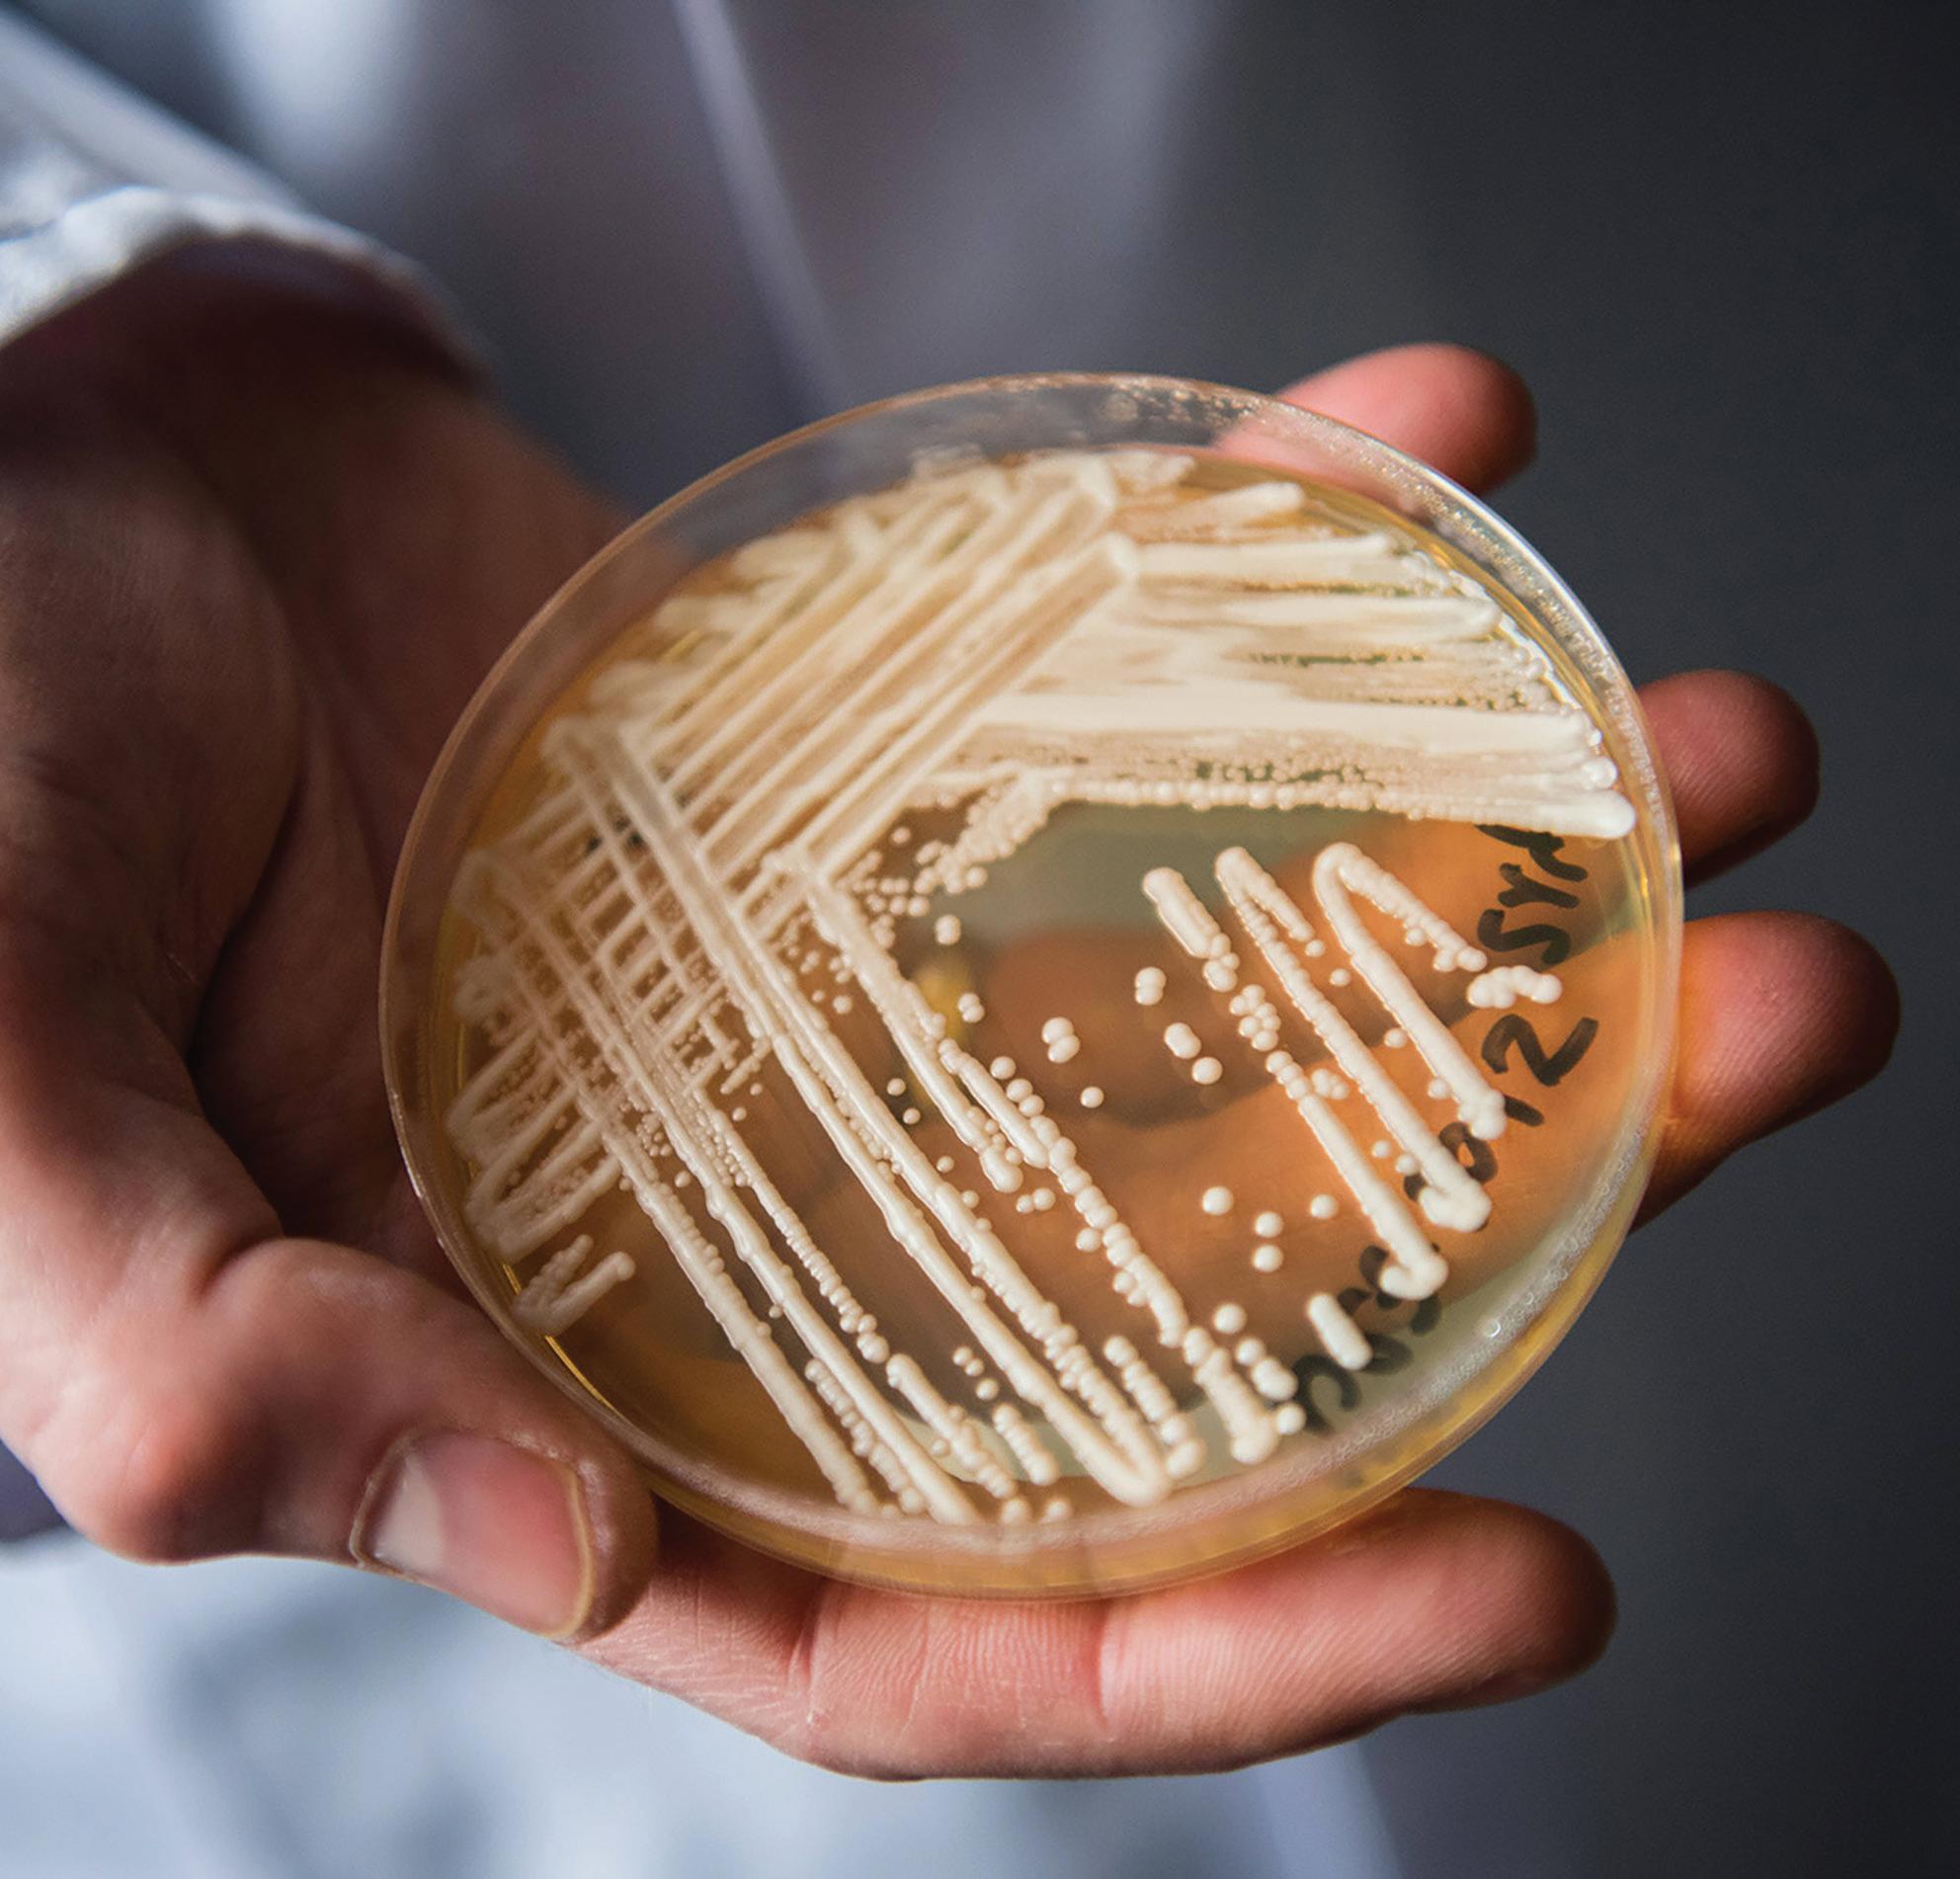

by




p.2-7
5
ESD brings Narcan, a new life saving drug, to campus; security and possibly teachers prepare to use it
7
Donald Trump is the first former U.S. president to face criminal charges in a trial over falsifying business records
![]()

by




p.2-7
5
ESD brings Narcan, a new life saving drug, to campus; security and possibly teachers prepare to use it
Donald Trump is the first former U.S. president to face criminal charges in a trial over falsifying business records
With Heil and Laba departing from ESD at the end of the school year, the upper school office gets ready to welcome two new faces
S tory by Brooke Ebner Web Editor
Josephine Mucciolo, upper school’s academic service coordinator, has walked into the upper school office every morning for the past six years ready to start her day alongside Head of Upper School Henry Heil and Assistant Head of Upper School Jeff Laba. But it will not be long before this changes, as next school year Mucciolo will be working with two new faces in the upper school office.
Both Heil and Laba announced that they will be leaving ESD at the end of the school year. Heil will be moving to Columbus, Georgia where he will start his new role as head of school at the Brookstone School on July 1. Laba will retire, after 34 years at ESD, at the end of the school year and will move in two years to Vermont with his wife.
Matt Peal was named the new head of upper school on March 9. For the past two years, Peal has been the head of upper school at the O’Neal School in Southern Pines, North Carolina.
“This is my second year of my second stint, so I started my teaching career actually at O’Neal,” Peal said. “I was an AP U.S. History teacher and baseball and basketball coach, [then I] left to go to graduate school and moved around to other various schools for the last few years, and then I came back two years ago.”
Peal grew up in Douglasville, Georgia, attended college at the University of Georgia and went to graduate school at Columbia University. He will be moving to Texas this summer with his wife and three kids who will attend ESD in the fall.
“I am most looking forward to meeting the faculty and staff, getting to know them, [and] I’m looking forward to getting to know the kids,” Peal said. “And [I’m looking forward to] my first Spirit Week and Friday night football game — those kinds of things where you just see the com-
munity in full force.”
Although Peal won’t officially start at ESD until the beginning of July, he has already begun connecting with the community.
“Mr. Heil has been really great about accommodating me, and he has invited me to sit in on various meetings, so I can get a glimpse of what they look like,” Peal said.
“I would say maybe once a week I’m sitting in on a meeting of some sort, whether it’s a faculty meeting or a student life meeting, whatever the case may be. They’ve been great about bringing me in and letting me see how things are working.”
Peal was drawn to ESD’s excellence in all areas of student life.
“ESD is kind of a renowned school [and] you all excel in almost every facet of school life, whether it’s academics or athletics or the arts,” Peal said. “And so you combine that with just an unbelievable foundation, [a] set of principles geared towards character development and inspiring and consciousness, a conscious mind, [and] those are all reasons for a guy like myself to be attracted to a school that works daily to help young people be better.”
Mucciolo thinks this transition will be similar to when Heil came to ESD.
“It’s just going to be a matter of making sure that [Peal] knows what’s going on and to stay on task,” Mucciolo said. “[It’s] pretty similar to when Mr. Heil came in because they don’t really know our community.”
Heil, although he wasn’t part of
“Anything I can do to serve the kids, the teachers and the mission, sign me up because I strongly believe in what we do in the long run.”
Max Augé upper school science teacher
the hiring team, has gotten to know Peal. He thinks that Peal’s prior experience and traits will make him a great new head of upper school.
“I think my sense is that he is a good listener, that he is really personal and approachable, [and] I think that he has a good sense of humor,” Heil said. “I think that he really likes upper school students. I think he’s been in education long enough to understand the nuances of what makes teaching difficult, but also what makes it so rewarding. He’s gonna be a really good partner for all the faculty, and I think he’s gonna be a great mentor and role model for all the students.” Mucciolo will also be working in the upper school office next year
Max Augé, who currently teaches upper school science and is an 11th and 12th grade advisor. Augé will take on the assistant head of upper school position as soon As Laba reires. Augé has been teaching at ESD for 15 years.
THE END OF AN ERA Henry Heil, Josephine Mucciolo and Jeff Laba hold a Friday morning meeting on May 5 and discuss plans for the day.
“I’m going to miss the daily unofficial check-in that we have with each other on both a professional and personal level,” Mucciolo said. “We review our calendars and offer any assistance that may be needed to get through our day.” Photo by Brooke Ebner
“I love this community, and I felt like I was well suited for the position,” Augé said. “Anything I can do to serve the kids, the teachers and the mission, sign me up because I strongly believe in what we do in the long run.”
Even though Augé will not be teaching next school year, he will still be able to interact with kids in the classroom.
“What I enjoy most is my interactions with kids in the classroom,” Augé said. “It’s the conversations, it’s the getting to know you, it’s challenging you, helping you reach your
goals, but I feel like I can still do that as the assistant head of upper school. I’m most excited about the fact that my classroom just got a bit bigger, [and] I see all 400 plus of you as my students, as my pupils, as my seedlings. Let’s just say that as my little seedlings that I can work and help you on your path to your full oak tree glory.”
Augé will be missed in the classroom. Junior Cara Lichty had Augé her freshman year in honors biology and also this year as her advisor and AP biology teacher. She likes how interactive and engaging he makes the class.
“Mr. Augé’s classes have always been my favorite due to his discussion-based teaching style,” Lichty said. “Rather than having us sit down and listen to a lecture or memorize a list of terms, Mr. Augé has us apply what we read about to the real world, helping us to refine our knowledge and apply it.”
Lichty also recognizes the care Augé has for his students’ success, either as a teacher or in an administrative role.
“Mr. Augé genuinely cares about his students, and he makes this clear by checking up on us and giving us advice,” Lichty said. “I think Mr. Augé’s caring and thoughtful teaching style will translate into him being the perfect person to fill his new position, giving a new meaning to discipline to students and teachers.”
Heil, who was a member of the hiring team for the new assistant head of upper school, was impressed by Augé’s questions during the interview process.
“He’s got a mind that is inquisitive and that’s gonna serve him really well in that role,” Heil said. “His vision for what the upper school could and should be was compelling. His name is one that emerges during senior exit interviews as one of the most influential teachers here at ESD and I think that demonstrates his connection with students.”


Since its debut on Jan. 15, the HBO hit “The Last of Us” has broken countless records and averages around 30.4 million viewers, surpassing shows like “Euphoria” and “Game of Thrones” in its first season.
This post-apocalyptic thriller takes place 20 years after a mutated Cordyceps outbreak, turning billions “infected.”
Joel and a 14-year-old girl, Ellie, survived and are humanity’s last chance at a cure after the fungal pandemic has swept the globe. Though this concept of fungi spreading to humans is almost entirely fictional, recent research suggests that a fungal outbreak on a massive scale may not be so far-fetched.
“I don’t know if it’s possible,” AP Biology teacher Max Augé said. “[But] it’s not out of the realm of possibilities.”
Fungal pathogens are becoming a more prominent health concern. In 2022, the World Health Organization released a list of 19 fungal ‘priority pathogens,’ based on several criteria.
The report said that “the prioritization process focused on fungal pathogens that can cause invasive acute and subacute systemic fungal infections for which drug resistance or other treatment and management challenges exist.”
Out of the 19 fungi, four are members of the Candida genus. Mild infections from other species of Candida appear in the mouth, throat and other parts of the body, and can be treated with over-thecounter medications.
Candida auris is ranked as the second most concerning pathogen on the WHO’s list.
Candida auris can cause deadly infections, and, as of now, there is no treatment. It is multidrug-resistant and spreads extremely quickly, especially in healthcare facilities because it can be carried on the skin without causing any symptoms. The CDC is especially concerned with this pathogen and emphasized that it is challenging to identify it quickly in healthcare settings.

Augé said that we have, in essence, created an environment where the fittest survive.
“Fungi change over time,” Augé said. “And we set up the conditions by using antifungal treatments for them to evolve a resistance.”
Auris is considered a health threat for three main reasons, but the most worrisome is the fact that it is often resistant to more than one type of antifungal drug.
“The problem with treating them maybe is that medicines that used to work won’t work anymore on them, if they should mutate,” science teacher John Gallo said. “It was pathogenic before, but there was medicine to treat it. But now, changes in the environment may be allowing them to reproduce and mutate faster.”
In the opening scene of “The Last of Us,” there is a fictional interview that dates back to 1968 with a group of scientists discussing what could prompt the apocalypse. When a character proposes fungi as a cause for the apocalypse, the audience laughs.
In that same scene, the scientist mentions Cordyceps, scientifically known as Ophiocordyceps unilateralis which is a real fungus that spreads to infect insects such as ants and spiders. According to the show, if the climate
MELTING GLACIERS Fungi from pre-human eras have been re-emerging from the ice as ancient glaciers, like this one in Ilulissat Greenland, have been melting faster than ever.
U.S. CASES The number of Candida auris cases has increased over the past few years
gets slightly warmer and the fungus were to mutate, it could spread and control the minds of billions, without a cure or treatment.
MIND CONTROL
Ophiocordyceps is a fungus that controls the movements of ants. Other strains of the same fungus manipulate different insects.
said. “Biology is meant to change over time.”
Global warming has helped this fungus to spread all over the world, but especially in the U.S., where Candida was mostly found in New York and Chicago in the past year. Now it can be found in over half of the country. The CDC published that the number of cases grew from 5,514 in 2021 to 8,131 in 2022.
There is some concern that global warming could be pushing fungi to evolve faster than ever before. Every individual fungus has specific conditions it prefers. Higher temperatures may mean water is more abundant, whether that’s from melting glaciers, lakes that are not freezing over or more rain.
“[And fungi] love really dark, moist areas,” Augé said.
The National Oceanic and Atmospheric Administration reports that rates of global warming have doubled since 1981, creating conditions that are more friendly to fungi. More available habitat gives fungi a safe space to breed, and higher temperatures are causing more activity.

“It’s the basic rule of biology, what happens to biological interactions at slightly higher temperatures,” Augé said. By adapting to survive under higher temperatures, more fungi might soon be able to survive in a human host, according to an article published in the Microbiology Society website.
At ESD, Nurse Marcia Biggs takes steps to make sure the nurse’s office is kept clean to ensure the health and safety of the school community.
“Lysol is my friend,” Biggs said. “And bleach. I love me some good one to 10 bleach solutions.”
Biggs also emphasized the importance of good ventilation and drying out surfaces, especially after heavy rain or flooding.

A zombie apocalypse caused by a fungus isn’t something that’s likely to happen in the near future, but Ophiocordyceps is a real fungus. This fungus stops ants on leaves precisely 25 cm above the ground, which is the zone where the fungi can best grow and thrive. Ophiocordyceps then takes control of the ant’s limbs and forces it to lock its mouth around the leaf. It grows through the ants’ head and releases fungal spores onto the ants below. Researchers have found evidence that
Source: CDC
this phenomenon is not one that evolved in recent years; this all happened over evolutionary time, which is coevolution, or the process by which the evolutions of two species affect each other. “That’s the function of biology,” Augé
“If you leave [fungi] on a dried out surface, they’re going to dry up and die,” Biggs said. “Just like you see mushrooms, they dry-out and die–kind of the same concept. So we try to dry things out with air purifiers, fans, that kind of thing.”
While healthcare workers are working to prevent the spread of fungal infections, we also have to try to protect ourselves.
“The other half of that puzzle is us as individuals taking responsibility for cleaning ourselves,” Biggs said. “A weakened immune system can make someone more susceptible to serious infection.”
S
tory and graphic by Alex Eastin, Reese Rawson and Valentina Boltchi staff writers
Tensions have been building as American officials threaten to ban TikTok, the popular app owned by Chinese company Byte Dance. TikTok has a large presence with over 150 million active users in the U.S. alone, according to CNN. American officials believe TikTok may pose a threat to American security, fearing Chinese authorities could use the app to gain American data.
Some senators are considering banning TikTok in the U.S. or proposing the sale of TikTok to an American company. According to The Guardian, countries like New Zealand and India have already banned the app, and the White House has considered following in their footsteps. The Trump administration attempted to ban TikTok in 2020, but this was shut down due to multiple court rulings. The Biden administration, however, has resurfaced the issue and is reviewing the situation due to tensions between the U.S. and China.
“If our country outlaws it, [ESD] will follow,” ESD’s Communications Director Julie Clardy said. “We have reserved our handle on TikTok, but we have no plans yet to use it as a presence.”
While TikTok doesn’t operate in China, its parent company, ByteDance does, and a very similar version of TikTok, Douyin, is available to use in China. Many are concerned that the app could be infiltrated by the Chinese government to either spy on American citizens or use the app to spread propaganda in the U.S. Lawmakers have recently renewed this issue after a report suggested that U.S. data had repeatedly been accessed by ByteDance em-
The annual Independent Schools Association of the Southwest Art Festival took place from April 13 to 15 at All Saints Episcopal School in Fort Worth, Texas. The festival has returned in full force for the first time since before Covid-19. Last year the festival only lasted one day and had a few schools attending. Forty-eight schools were represented and nearly 4,000 students attended the event.
At the festival, students were able to view other schools’ work, leave notes for other students on their artwork, attend performances or sunbathe on the grass with a nice cold snow cone. For the rest of the time, performing arts students performed for crowds and received critiques.
“I worked with an accomplished adjudicator who has a Grammy nomination under her belt, and she worked a lot with me to further develop my vocal technique,” junior Brayden Girata said. “She even performed an exercise with me that I had never done before: she pushed my chin back as I sang to lower my jaw and create a more ‘free’ timbre in my sound.”
Non-performing arts students also received critiques, and photography, 2D and 3D art students participated in a portfolio review and spoke with professionals.
“Initially, I was worried my critique would be harsh and unpleasant; however, the feedback I received included praise as well as constructive criticism,” Morgan Amison, junior and AP 2D art student said. “[It] focused on holistic improvements such as use of light and space as opposed to a critique on my literal drawing or painting skills, which are still developing as I practice more and more.”
ployees. But at the heart of all these problems lies the laws of the Chinese Communist Party.
“China has national security laws that require companies under its jurisdiction to cooperate with a broad range of security activities,” Catherine Thorbecke, CNN writer who specializes in business and technology stories, said in an article.
This poses a threat to the U.S., as the Chinese government could have leverage over TikTok or its parent company at any time. American officials work to find out if and how that leverage has been used.
According to CNN, some security and privacy directors have stated that TikTok doesn’t differ from other social media networks in terms of the data that is collected from their users.
Montana was the first state to approve a full ban on TikTok on April 14. The bill makes it illegal to download TikTok in the state, with penalties of up to $10,000 a day for any entity, such as Apple, Google or TikTok, that makes the popular video-streaming app available, according to NPR. If enacted, the ban in the state would not start until January 2024.
Freshman Jay Miller is an avid user of the app, spending many hours a day watching and making TikToks.
“They have everybody’s information, so I don’t really care if they have my stuff too,” he said. “What would China do with our information?”
According to the BBC, Republicans and Democrats came together on March 23 in a congressional hearing to question TikTok CEO Shou Zi Chew. Chew told politicians the Chinese goverment never had access to American data.
“They have never asked us, we have not provided it,” Chew said in an article for People Magazine. “ByteDance is not an agent of China or any other country.”

To abolish these safety concerns, TikTok has announced “Project Texas,” which will move U.S. user data outside of China to Texas. Project Texas initially earned its name in 2020 when Austin-based company Oracle won out to serve as TikTok’s U.S. technology partner.
Politicians, however, are still unsure if Project Texas can be accomplished by the end of the year.
Politicians are also concerned about TikTok’s ability to spread dangerous information to the many young kids on the app. Chew emphasized that the company does its best to remove videos that go against the apps’ community guidelines. TikTok has recently created a $1 billion creator fund, where money is paid by TikTok directly to its content creators to keep them posting frequently on the app. Many other Americans find the creator fund heavily beneficial. Sproutsocial, a social media management company, states in their website that the apps’ posts make users inclined to buy a product.
“Forty-nine percent of TikTok users said it helped them make purchase decisions,” writer Carly Hill said in a “What is TikTok?” article published on Oct. 11, 2022.
Freshman Michael Peralta has no social media presence and feels TikTok should be banned.
“I can see the addictive factor of [TikTok], but I feel like there’s also some clear points that are too addicting at some point,” Peralta said. “I feel [the TikTok ban] is completely right. There has been some data encrypting, data stolen, and it’s too addictive.”
Small business owners, however, find TikTok a useful platform to advertise and sell their products. It is a convenient alternative to expensive marketing techniques because of its widespread influence and diverse content. Therefore, many TikTok users have been in a frenzy over the recent possibility of a ban.
“I [will] use a VPN to get around it,” Miller said. “I [enjoy] watching the funny videos.”
Teenagers around the globe use TikTok so much that banning it will push many to pursue extreme measures to make sure they are still able to use the app. Many believe that TikTok poses no real threat to American security, and they are concerned about the possible violation of First Amendment rights outlined in the American Constitution. Others believe banning the app is the safest option to protect American security from foreign influences.
“TikTok has had a chance to take down all of their horrible challenges, rephrase their system, and stopped dating hacking, but they didn’t, and it’s still happening,” Peralta said. “Until [TikTok] fix[es] it, then I’m not going to defend [it].”
news briefs a deeper look at current events and happenings on 1400 Merrell Road
In recent months, the Dallas Police Department has set up a selective traffic enforcement zone, more commonly known as a speed trap, outside of campus. This was not set up by ESD but by on-campus officers that observed the frequent speeding on Merrell Road.



1 EYEING THE ART
Seniors Cecily Northcut, Beatrice Bryan and Elizabeth Goelzer assess student artwork at ISAS on April 14.
Changes in uniform policy allow students the option to wear polos next year.
“Officers noted that traffic was going way too fast through the school zone, and many people were not paying attention to the road because they were on their cell phones,” Jody Trumble, director of campus security, said. “Because we have so many people crossing the street on Merrell Road and cars slowed or stopped waiting to turn into the campus, the speed of those vehicles moving through the school zone made the situation more dangerous.”
Students, teachers, parents and other drivers have been caught speeding in this school zone. So far, 24 people have been caught. Twenty-one speeding violations were reported in five days.
“One day, I only concentrated on students. Parents [were] complaining that students were the problem, turning into Gate Eight, which resulted in no speeders,” Senior Corporal in the DPD Justin Parker said. “The vast majority of violators were parents.”
Officers have been on campus since Fr. Stephen Swann was head of school. He was able to create a strong relationship with the DPD before many other private schools in the area. Now, ESD has Hill Martin ’10, a DPD officer and alum, who serves as the officer coordinator.
“[Swann] wanted the extra layer of protection that a relationship with local first responders would entail, but also wanted our kids to see and know police officers in a different way,” Trumble said. “Not just as authority figures, but as members of our community, helpers, protectors, and humans. We keep our police officers on campus because not only is it now a best practice, but because they are so much a part of ESD’s culture.”
On April 24, Ruth Burke, Associate Head of School, announced that the next school year will feature a few changes to the uniform. This decision was made after many meetings with teacher and student focus groups.
“The 14-member faculty and staff team came to a consensus through in-depth discussions on uniform recommendations,” Burke said. “Those recommendations were then shared with the Executive Leadership Team for approval.”
There will be two waves of change. The first wave will come in the 2024 school year; middle school students will have the option to wear navy polos and high schoolers will wear white polos.
“The uniform next year will be more modern, up-to-date and comfortable compared to now,” junior William Lett said. “Ever since I’ve heard about it I have been looking forward to new uniforms because they just seem overall better. I don’t think the senior privilege is threatened as it has always been the difference in color rather than the polo itself.” The second wave will come in the 2025 school year. The extent of the change is unofficial as of now, but the final plan will be shared on Oct. 15. So far, the administration is thinking of changing the skirts to be more athletic, the blazers to feature the school crest, adding dress shoes or Sperrys on formal days and adding more zipup options on non-formal dress days.
Briefs by Iris Hernandez Managing Editor
Proposed California law could ban five of these ingredients in the next few years
S tory by Emmy Moss, Harper Sands and Ryder Sands staff writers
It turns out that the Skittles’ slogan “Taste the Rainbow” is not so colorful after all. California is trying to pass a bill that would ban the manufacturing, distribution and selling of the candy and any other products containing five chemicals that have been linked to health problems. This bill, which would go into effect on Jan. 1, 2025, will make California the first state in the nation to ban these five chemicals.
According to CBS News, California’s Assembly Bill AB 418 advocates the ban on the manufacture and distribution of food containing red dye No. 3, titanium dioxide, potassium bromate, brominated vegetable oil and propylparaben.
Kelly Gubert, ESD parent and registered dietitian in Dallas, believes that Texas does not have legislators ready to back bills like the one in California.
“Texas is so poorly lacking in support overall for things like our nutrition support systems,” Gubert said. “I really hope it starts in California because if it starts somewhere in the United States, I think that’ll help push forward [and] other states [will] do it.”
Upper school chemistry teacher Anneke Albright said that these chemicals are being flagged as carcinogens in the respiratory system.
“When your body is breaking down these molecules, they break [it] down into nanoparticles,” Albright said. “Those nanoparticles, which are obviously very, very teeny, can accumulate in your lungs over time, kind of like someone who smokes once a week versus 10
years; you can see the difference in their lungs. The accumulation of all those poisons over time has to do with what your timeline is. If you were to [eat a] pack Skittles every day, you [would] probably have a concentration of those particles built up in your system because once your body breaks it down, it can’t break it down any further. It doesn’t know what to do with it. It just stays there.”
While the entire population can be affected by the consumption of these chemicals, kids are more vulnerable.
“Young children are the ones that are most affected because of their small body weight and because they are exposed to much more of these dyes in food,”
Tasha Stoiber, Ph.D., a senior staff scientist at the Environmental Working Group, said during an interview with Consumers Report in February. “Even small amounts of the dye can add up and pose a risk to kids.”
Red dye No. 3, for example, is used in thousands of popular products, such as drinks, foods, candies and even cough medicine. Skittles, Hot Tamales, Nerds candies, Trolli gummies, Nesquik, instant rice, potato products, protein shakes and boxed cake mixes use this dye as an ingredient. According to the FDA’s estimation, “American children ages 2 to 5 end up consuming twice as much red dye No. 3 as the general population on a body-weight basis.”
“Even small amounts of the dye can add up and pose a risk to kids.”
Tasha Stoiber senior staff scientist at the Environmental Working Group
The California Office of Environmental Health Hazard Assessment reported that excessive amounts of red dye no. 3 causes hyperactivity and other neurobehavioral effects in children. However, according to The International Association of Color Manufacturers, consuming red dye No. 3 “is safe in levels that people can typically handle.”
There is a reason why food manufacturers in the U.S. use these controversial ingredients.
“It is cheap to manufacture,” Gubert said. “It makes them last long on the shelves as well as [looking] more appealing to [the] consumers.”
Gubert believes that if these foods remain a part of the American diet, over time, these chemicals will cause major health problems. There are many additives and ingredients that are controversial in the United States and are already banned across the globe. Gubert gave the example of the popular Kraft Mac & Cheese, which is sold in the U.S. and Europe.
“Mac & Cheese, [the kind] that you buy in the store in the box, has yellow food dye in it,” Gubert said. “Kraft sells Mac & Cheese in Europe without the yellow dye in it. So they have a formula they make for Europeans. They make it for Americans with the food coloring.”
Potassium bromate, a dough
strengthener found in flour products, is another harmful additive. In an interview with CBS, Professor Eric Millstone from the University of Sussex in England, said that this ingredient is banned in Europe, China and India.
“There is evidence that it may be toxic to human consumers, that it may even either initiate or promote the development of tumors,” Millstone said to CBS.
Millstone also said that it is almost certain that Americans were likely unaware that they were being exposed on a daily basis to substances in their food viewed as dangerous in Europe.
However, potassium bromate is not the only chemical still used in the U.S. and banned in other countries. Titanium dioxide, brominated vegetable oil, potassium bromate, azodicarbonamide and propylparaben are examples of ingredients that are used in the U.S. but not in Europe.
Melanie Benesh, vice president of government affairs at the Environmental Working Group, said in an interview with Food Navigator that there are alternatives, such as starch-based options, that could be used to give foods a similar look and taste without the need to use the controversial additives.
However, according to Albright, it is important to remember that foods containing these ingredients are not necessarily poisonous.
“There’s a lot of chemicals in there that you are not biologically predisposed to process,” Albright said. “But that doesn’t mean when you eat it once, you’re going to get cancer. So, if you want to eat foods and drinks containing it, the key is having it in moderation.”
Amidst an opioid crisis, Narcan is introduced at ESD with security staff trained to administer it
Only 20 minutes away from ESD, at Dewitt Perry Middle School in Carrollton, staff members used Narcan to revive a student from an opioid overdose on April 4. That is the second time in recent weeks that a student’s life has been saved by administering this drug in the Carrollton ISD school district. Here at ESD, Director of Campus Security Jody Trumble helped make the decision to bring this life-saving drug onto our campus.
“I think pretty much anytime you turn on the local news in the evening, you hear about another person or another young person who has been taken by an opioid overdose,” Trumble said. “It’s sad that that person could have been saved by something that you can now get for free.”
According to the Substance Abuse and Mental Health Services Administration, Narcan, or naloxone, is a synthetic drug similar to morphine which is approved by the Food and Drug Administration. It is designed to block opiate receptors in the nervous system to rapidly reverse opioid overdose by attaching to opioid receptors and reversing their effects. Naloxone may restore breathing to a person if their breathing has stalled or stopped due to an overdose.
“We used the Red Cross to complete our training,” Marcia Biggs, the school’s nurse, said. “There are multiple opportunities available
though. The CDC has some free training. Once you complete the training, you receive a certificate of completion. We consider that approved to administer it.”
ESD received packages of the drug from an organization that has a mission to deliver and keep Narcan in schools without purchase or payment.
“Why would we not have that opportunity?” Trumble asked. “Even if we have it on campus and we never use it, which is the goal, right? It’s here forever, and [if] we never have to use it. Great. But if there was one chance that we can save someone’s life because we had this tool, then I think we would be remiss not to have it.”

This being said, naloxone should not be treated as a medicine for opioid overuse and will have no effect on someone who does not have opioids in their system.
Another factor that was consid-
ered when making the decision to bring Narcan on campus was that there might be the need at some point to administer the drug to people who might be visitors on campus.
“We have people on our campus all the time, not just our student population,” Trumble said.
“We have people who come in for games and people who are here visiting, and we don’t really know anything about them. To have that tool on our campus to be able to possibly save someone’s life was really important to us.”
Opioids are a class of drug that includes synthetic opioids such as the lethal fentanyl, legal pain relievers such as oxycodone, Vicodin, codeine, morphine and illegal drugs like heroin. Teens may run into a drug problem if they gain access to drugs by sharing or selling their prescribed medication, also known as “diversion.” The National Institute on
Drug Abuse found 57 percent of 12 to 17-year-olds who abuse or misuse prescription opioids got them from a friend or family member.
Another concern is accidental opioid addiction in teens. An addiction may start after students are prescribed opioids for pain after an injury, surgery or even dental work. People can become addicted even though it is not prescribed or needed any longer. The Center for Disease Control and Prevention reported that more than 10 percent of adolescents in the United States were prescribed some form of an opioid in 2018.
A way to combat this potential opioid misuse before a surgery would be to educate teenagers on pain control and the effects of the medication they are using. Encouraging them to be open about their concerns and symptoms can help to curb any potentially harmful behaviors.
“I think it’s important for people to be honest about the medications [drugs] they are taking,” Biggs said. “No stigma and no judging. If you have questions, ask a trusted adult.”
The school decided to get Narcan just to be prepared in case of an emergency.
“When you start looking at the number of incidents that happen around even just the metroplex, it was important for us to say ‘this is important,’” Trumble said. “We need to have this.”
Amy Heller displays courage by talking about her terminal illness during her visit
S tory by Maggie Pickens staff writer
On March 29, Amy Heller, the retired ESD senior chaplain, visited campus and talked to students and staff during Chapel about leadership and perseverance. She shared her story about battling cancer with the community.
“It felt wonderful returning to ESD,” Heller said. “Being able to return and see you all was a true blessing.”
During her time as chaplain, she inspired and impacted many. English Department Chair Tolly Salz said that Heller made everybody feel welcome, especially in the chapel.
“[It was] just her humor and her generous heart,” Salz said. “I think that she is a very wise person. She has a beautiful calm and a great optimistic spirit. That has always comforted me.”
Language Department Chair Laila Kharrat, who is Muslim, agrees and said that Heller helped her feel comfortable talking about her own religion in an Episcopal school.
“She encouraged me year after year to speak in chapel [and] to share [my religion] with the community,” Kharrat said. “I finally had the courage to speak in chapel, which was while she was still here. It is one of the most proud moments of my life. I felt like not only was I sharing a big part of my identity with the community, but I felt like I took a step that was courageous, and I put myself on the line.”
Current ESD Senior Chaplain
Fr. Nate Bostian has been close to Heller since the early 2000s when they met. Since then, he said that she has greatly impacted him on his ministry path.
“She has been an incredible mentor for me whenever I was a college minister before I was ordained into the priesthood,” Bostian said. “She showed me a lot of what it means to be a priest, [and] how to do ministry with people. She showed me how to celebrate the sacraments in beautiful and life-giving ways. Her mentorship has profoundly impacted me.”
Heller was happy to have a chance to talk with Fr. Bostian during her visit.
“The next most exciting thing was to catch up with Fr. Nate on how his ministry [at ESD] among you is going,” Heller said.
Over the years, they got very close and encouraged each other, even outside of the ministry world.
she was struggling with,” Bostian said. “We shared a lot of different ideas about how to overcome those things.”
Heller greatly valued the ESD community and worked to strengthen the community bond. She helped bring the lower, middle, and upper schools together by being a full-time chaplain for all three divisions.
“ESD was six years of incredible ministry for me,” Heller said.
“God loves you and is with you always. I believe that very deeply...There is so much noise in our daily lives these days, and Jesus sets a strong example of walking with [us].”
Amy Heller retired ESD senior chaplain
“As I got ordained and got into [being a] school chaplain, I had many, many conversations with her about different things I was struggling with; about different things,


Santiago Peña emerged victorious in the Paraguay election on May 1, continuing the 70-year domination of the Colorado Party. Peña, an economist, earned 42 percent of the vote, with his opponent of the Concertación Nacional, Efraín Alegre, receiving 28 percent of the vote. Despite the high levels of poverty and corruption in Paraguay, the economy is expected to grow with Peña in office. Further, it’s expected that ties with Taiwan will be maintained with Peña as the new president rather than Alegre.

On May 6, King Charles III and his wife Queen Camilla were crowned at Westminster Abbey. More than 2,300 diplomats, world leaders and celebrities filled the congregation for the first coronation in the UK in 70 years, alongside thousands on the streets. President Biden did not attend the event but his wife, Jill Biden did. Prince Harry did not join the Royal Family on the balcony after the coronation ceremony. Keeping with tradition, King Charles III was anointed with oil from the 12th-century coronation spoon and wore Saint Edward’s crown for the first and only time in his career. The Royal Air Force did a flypast after the ceremony was completed, with jet streams of red, blue and white.
NOW AND THEN LEFT: Fr. Nate Bostian sits with Mother Amy Heller while she preaches to the Upper School during her visit on March 29. “To have served alongside faculty and students who wanted to grow, that has meant the world to me,” Heller said.
RIGHT: Jody Trumble jokes with Mother Amy Heller about carpool safety while it was raining in the fall of 2017. “It was pouring rain so hard that we were joking we needed those to do
said. Photos provided by the communications department
“I was brought in to deepen the roots of our Episcopal identity and then help us become one campus, and those were passion projects for me. I find my call to ministry has always involved teaching about the love of God for everyone and for building a community that respects the dignity of its members.”
Heller supports everyone that she encounters in her life. Bostian said that she always was “incredibly encouraging” to him.
“She is a person who will identify your gifts, affirm those gifts, and encourage you to use those gifts,” Bostian said. “But she’s also a person who is a really good coach; she will note whenever she sees something to be improved.”
Originally, Heller planned to visit last spring, but her treatment made her weak. Heller said she was excited to come to ESD this spring.
“I think the most exciting part was simply being with you all after two years away,” Heller said.
Heller was diagnosed with metastatic breast cancer in September 2020 but had been in remission since her initial breast cancer diagnosis in 2001. In January 2021, she resigned to focus full-time on her medical care.
Kharrat appreciated Heller’s courage and bravery in talking about her terminal illness.
“It’s humbling when somebody who knows that they’re not gonna make it is coming with a smile on their face and saying, ‘God is with me, and I’m with God,’” Kharrat said. Salz agrees, remembering her courage and accomplishments as a chaplain.
“She is a very strong woman,” Salz said. “She’s a very smart woman. And she’s got incredible faith and heart to give to others even when she herself might be struggling.”
Throughout her treatment, Heller’s history as a chaplain and her strong faith in God helped her remain centered.
“God loves you and is with you always,” Heller said. “I believe that very deeply. I also wanted to convey that one part of leadership is to be a voice and advocate for those whose voices are trying to be heard in a community. There is so much noise in our lives these days, and Jesus sets a strong example of walking with [us].”


Eight were killed and seven were wounded at a May 6 shooting at the Allen Premium Outlets Mall, with the youngest victim being 5 years old. Pedestrians and shoppers scrambled to storage areas, remaining hidden for up to two hours. The gunman was dressed in black with body armor, and he used an AR-15 style weapon; he was neutralized by a local officer. This attack marked the 199th mass shooting in the U.S. in 2023.

Syria was readmitted to the Arab League on May 7, after 10 years of absence due to its civil war conflict. The timing of Syria’s return is controversial, as an Arab League meeting is scheduled for late May in Saudi Arabia, which Syrian President Bashar al-Assad can now attend. The decision was reached by 13 nations in Cairo, Egypt, in the interest of gradually reprimanding the Syrian civil war and drug smuggling issues.
S tory by Lauren Shushi Views Editor
Donald Trump was indicted on April 4 following an investigation looking into a hush money payment to adult film star Stormy Daniels.
The payment was made out for $130,000 and was paid by Trump’s then-personal attorney
Michael Cohen in late October 2016. The wire transfer came just 12 days before the 2016 election that Trump won against Hillary Clinton.
Sophomore and member of the Conservative Student Union Katherine Clark believes that Trump’s arrest will only inflate his supporters and political party.
“I would say that the arrest kind of riles up the Conservative Party,” Clark said. “And the people who back Trump, I read, are just funding him even more now.”
Trump is the first former United States president to face criminal charges, though the exact details would not be released until the time of his arraignment — when the indictment will be unsealed. Prosecutors accused him of being involved in a scheme to cover up potential sexual scandals during his presidential campaign. He has been arrested and charged with 34 felony counts of fraud in a 16-page-long indictment report. Trump, denying all allegations of an affair with Daniels, pleaded not guilty to the charges of falsifying business records.
“I feel like it’s a little excessive with the 34 charges against him,” Clark said. “Thirty-four charges. That’s a lot, and I don’t know if it’s possible for someone to hide that many business documents, but I think that if that is really the amount they found, these documents should be released to the public.”
In 2018, when Cohen pleaded guilty in federal court, he pointed the finger at Trump, saying it was he who directed the payoff to Daniels, a claim that federal prosecutors would later confirm. “Hush money” itself is not illegal, — as long as the
nected to a crime, or does not otherwise violate the law — but the money was looked into due to the method of payment and unlawful activity surrounding the act. The legal recording of Cohen’s reimbursement sparked the investigation, as Cohen falsified business records, saying that the payment was for legal fees.
Upper school history teacher Adam Walsh, who studied law at Wisconsin University and was a prosecutor in New York for around seven years, does not expect the prosecution and defense to agree on a plea deal.
“Ultimately, I cannot believe that the sides will reach a plea agreement,” Walsh said. “In this case, I would be 100 percent shocked if that were to happen, just given the stakes that are involved here because a plea requires the defendant to accept responsibility. And that would most likely have political ramifications for the future.”
Senior and member of the Progressive Student Union Bridget Wang believes that the court system is just and necessary, and the outcome of the case will be up to the law.
ue is considered a long shot but was argued because Trump does not believe that he can get a fair trial in Manhattan, where he thinks he is unpopular. He suggested instead moving the trial to Staten Island, a more conservative borough than Manhattan.
In the 2020 presidential election, Biden won Manhattan with 84.5 percent of the vote to Trump’s 14.5 percent. However, Trump won Staten Island with 61.6 percent of the vote to Biden’s 37.6 percent.

“I think the justice system is really necessary,” Wang said. “I think people obviously need to be held accountable for their actions regardless of whether you’re a public celebrity or politician. Everyone should be held accountable for their actions. And in that light, I think that the case is a necessary process that Trump has to go through.”
Trump’s legal team is looking into two options for the betterment of their defendant: a motion to dismiss the case, having the charges thrown out completely, or to have the case moved to a different court, called a change of venue. The first movement is often handled by lawyers and rarely results in a dismissal. A change of ven-







“VERY UNFAIR VENUE,” Trump wrote in his social media app, Truth Social, on April 4. “WITH SOME AREAS THAT VOTED 1% REPUBLICAN. THIS CASE SHOULD BE MOVED TO NEARBY STATEN ISLAND - WOULD BE A VERY FAIR AND SECURE LOCATION FOR THE TRIAL.”
When Cyrus R. Vance Jr. was the Manhattan district attorney from 2010 until 2021, he opened the investigation into Trump while he was in office and wrote in an email to KCRA Weather and News that he believed Trump’s lawyers would file a venue change.
“Change of venue motions have been granted, of course, but very rarely,” Vance said. “Pretty much anywhere or everywhere this case is tried, one can make the argument that jurors will either be biased for or against the former president.”
Vance said it is up to the judge and lawyers of the case to choose jurors that can compartmentalize their personal bias with the facts of the case.
“Many cases involve facts so well known that everyone will have heard of the case,” Vance said. “The jury selection process by the judge and the parties is to find jurors who

are willing and swear to put aside anything else but the evidence they hear in court and the instructions on the law by the judge.”
Walsh is of the same opinion as Vance in the fact that a difficult aspect of the case will be to find willing and able jurors.
“The hardest part in this case, if it goes to trial, is that you are going to have to find a jury that is impartial and willing to try this case,” Walsh said. “That will be so hard. You’re going to have to find the 12 people with zero political interests whatsoever. A normal jury selection is around two hours, I’m going to say this will take around a week.”
Falsifying business records is usually charged as a misdemeanor, and the charges against Trump are the lowest category of felony in New York, carrying a maximum sentence of four years per count. Even so, time behind bars is unlikely to occur, and the most likely outcome will be a fine.
“Falsifying business records is only a felony if it’s to cover up another crime.” Walsh said. “Now, if he were to be convicted of only falsifying business records, then it’s a misdemeanor and then you are definitely just looking at a fine. That’s a case where it’s certainly a decisive loss for the prosecution. In the end, it may end up just being a really big fine, which, in normal defense situations they probably would have agreed to in the first place.” Wang believes that this case, in the end, should be a move towards a less polarized political environment.
“I think in today’s political climate, the two democratic parties are really divided,” Wang said. “So hopefully, at the end of this, we can sort of come together and start to compromise. That’ll be up to our politicians and whoever is in charge, but I think this indictment case is just really just giving another example of how people need to be held accountable, regardless of political parties.”





p.8-16
9
As the school year winds up, seniors and their friends celebrate graduation with large parties or small gatherings
Junior Austin Stibbens scrolls through Instagram, cars fly by, but none are quite what he’s looking for. Suddenly, he sees it — a sports truck from the 1990s. He runs to show his dad, his father’s eyes dart across the screen, and a wide grin covers his face; he’s found it, the inspiration behind his next project.
The project? Stibbens first car: a car he’s going to build.
“[My father] had a sports truck when he was my age in the ’90s, and his friends did too, it was a very big thing,” Stibbens said. “We talked for hours about them and what would be cool to do, and then from there, we made a plan and never looked back.”
A sports truck is a modified version of a truck. Stibbens added different wheels, interior, engine, speakers and radio than the original truck came with.
Building a truck is a long process. Stibbens and his father started by buying an old, dirty 1996 Chevy truck for $2,500 that didn’t run. They had seen it around town, just sitting in the front yard of a neighbors house, and knew that they could buy it for cheap. So, they went up to the front door and knocked and asked to buy the truck. The neighbor agreed. They began by stripping the car down to bare bones. They only kept the cab, the bed, the doors and the frame.
“It’s a lot easier than putting it back together,” Stibbens said. “It’s actually the easiest part. It only took about a month.”
However, disassembling it wasn’t all that easy. To take out the engine, they had to separate it from the transmission, both of which were extremely heavy.
“You kind of have to grab part of the transmission to lift it up and turn it into the right position to be able to separate it,” Stibbens said. “There is no good hand placement to grab it. It sucks because you are holding this, thinking, ‘I’m about to break my feet and every other bone in my body.’”
All in all, he has been building for a total of six months; however, he
hasn’t been working on it the whole time. Life just gets in the way.
“The reason for it taking me so long is because things are expensive, it takes a while to get parts, and you only have so much time in a day,” Stibbens said. “I’m so busy with school and sports and all that I do, so it makes it very hard to work on it every day that I would like to.”
So far, Stibbens has spent approximately $5,000 to $6,000 on the car, which is around the average for a car that is built at home, according to Stibbens.
“This is the part that hurts the most,” Stibbens said. “When building a car, you can either do it the cheap way or the right way. We chose to do mine the right way and pay for high value and highly rated parts, basically all legit, all name brand, top of the line stuff.”
ate my car…Well, maybe a little bit.”
Stibbens father is a car fanatic and has had a lot of experience with cars, making him knowledgeable about the car building process and a great teacher for Stibbens.
“My dad has been working on cars long before my time, and he himself is a pretty big car guy,” Stibbens said. “Throughout my early years, I would always watch him work on different cars, and if you listen and look closely enough, you might just learn something.”
“I don’t really like just being handed stuff, I was brought up on the principle that if you want something you have to work for it.”
In order to pay for car parts, they bought another 1996 Chevy truck for $1,500 that also didn’t run, which he and his father scrapped for parts they needed, and they sold ones they didn’t need.
“I had more money and more parts to continue building my car,” Stibbens said. “That made me happy.”
They then took the frame that they had to get powder coated to prevent rust. They then put in a C-notch which makes the car sit lower.
“[The C-notch] is just a part of the style,” Stibbens said. “It looks cool and also helps with aerodynamics.”
Stibbens and his father then began putting together everything. The car has a 454 super sport engine and is capable of racing.
“I don’t plan on racing it,” Stibbens said. “I have grown to appreci-

Austin Stibbens junior
His father, Justin Stibbens, has always been around cars and people that love them. Uncles and other family members were into hot rodding and racing, so he learned a lot from them.
“When I was around 10 years old I met a buddy of mine that I still talk to today that had a large collection of antique cars,” Mr. Stibbens said. “We worked on those cars all through our teenage years, even up to today. We, along the way, bought and sold cars through his dad’s dealership and worked on them there. [We] also bought and sold our own cars that we worked on and played with as well.”
Since many in Stibbens’ family are passionate about cars, Stibbens felt like he had to learn as well. According to Mr. Stibbens, building cars has taught his son valuable life lessons along with valuable skills.
“[I taught him] so [he] can see how much time and effort it takes to do a project like we are doing, so [he] will respect the project more… no matter if it’s a car or whatever [he does],” Mr. Stibbens said. “[Building cars] definitely teaches you patience and the unexpected and how to get around it. [Also to] be resourceful from us going to junk yards or whatever it is. It also [and]
AUSTIN THE BUILDER
LEFT: Junior Austin Stibbens buffs the 254 engine for his car in preparation for new seals.
“We just got done cleaning up the engine and now we’re putting it back together,” Austin Stibbens said. RIGHT: Stibbens basketball court was converted into a workspace to build his car.
showed you what planning a project like that takes and, when you’re done, a sense of accomplishment. Anyone can hand you a set of keys, but it’s different when blood, sweat and tears are in it.”
Sports trucks were a trend that began in the 1980s and lasted for nearly 20 years after. In the 1970’s there was a gas crisis due to the Yom Kippur war and the Organization of Arab Petroleum Exporting Countries placing an embargo on any countries allied with Israel. Horse power and emissions were limited for cars which greatly affected the hot rodding industry as they were forced to make more fuel efficient cars. However, the industry found a loophole. It only applied to cars, not trucks. People were free to modify cars as they pleased. Dodge came out with the little red express, and it became their latest muscle car. Other companies began to release similar trucks. In 1988 Chevrolet and GMC came out with their new line of trucks which had many of the characteristics of a sports truck.
Soon, Boyd Hot Rods got a 1989 GMC. Craig Meredith created the first chopped Old Body Style truck. He took this truck, shortened the frame and dropped it. He also gave it a new custom grill, tail lights, interior, a vibrant paint job and custom wheels.
“They got the truck entered into a magazine and people went bananas [because] they think it’s the coolest thing they’ve ever seen,” Stibbens said. “Everybody asked him if they could get their truck done like that.” The sports truck movement boomed. It became mainstream to have a decked out truck. Soon dealerships became involved. Chevorlet worked closely with professional hot rodders and had in house hot rodding services placed at dealerships.
A car that had a lasting impact was the BellTech Splash Truck. It was a Chevy truck that was built for a popular car show in 1990. It had a turquoise base color and a bright magenta splash on the front and on to the sides. The sports truck industry has fizzled out, but there is still hope, due to the 90s resurgence, that sports trucks will come back.

S tory by Brooke Ebner Web Editor
Camie McKee ’09 was back at Camp Waldemar in Hunt, Texas in April 2022, a summer camp where she, her mom and her grandma spent their childhoods. This time, however, she was back at camp for a different reason. She was there as a bride surrounded by her family and friends.
As the school year winds down and summer approaches, many students get excited to return to summer camp. Whether 8 years old or 18, many decide to spend time during their summer away from home and the internet.
According to the American Camp Organization’s 2016 Camp enrollment survey, about 80 percent of the camps that responded, reached the same or an increase in enrollment than prior years. In a May 10 survey of 78 upper school students, 20 percent of respondents said they are going to sleepaway camp this summer, 35 percent used to go but don’t go anymore and 3 percent are returning to camp as a counselor.
Some campers like McKee have such a strong connection and memories from their camp days that they decide to get married there. Kaki Miller ’14, got married on April 29 at Camp Waldemar as well after being a camper there for eight years and a counselor for four. A lot of the friends she made at camp were also at her wedding.
“My mom went to the camp and her mom signed her up for it so that’s how I learned about it,”
Miller said. “My mom signed me up when I was zero, she put me on the waitlist when I was little bitty, and then she took me to go visit the camp when I was probably six or seven. I fell in love with it.”
Senior Lyles Etcheverry will be returning to Camp Mystic, an all-girls Christian camp in Hunt, Texas, for her 11th summer. However, this year will be her first as a counselor.
“I really like the friends I’ve made,” Etcheverry said. “It’s kind of been the only reason that’s taking me back every year. I’ve just made some of the best friends in my life through camp.”

Claire Mrozek, upper school history teacher and junior class dean, went to camp for 10 years as a teen. For her first two years she went to a camp for two weeks and when she was nine, she started going to Camp Island Pines in New Hampshire for a month and then
two months when she reached the age of 12 or 13 and then went back as a counselor.
“I was a pretty active kid and I loved the idea of having different activities like archery, canoeing, sailing and hiking,” Mrozek said.
“I liked being outside [and] I wasn’t fussy, so in sort of not luxurious circumstances wasn’t an issue for me. My mom worked, so it was a fun way for me to spend my summer [and] much more fun than what I would have been doing at home.”
Mrozek also went back to camp as a training junior counselor, senior counselor and would have been a head counselor, but the owners closed the camp when she was 17. Mrozek feels that her time at camp as a counselor introduced her to leadership skills.
“I didn’t know that I wanted to be a teacher when I was that young, but I think that it introduced me to a lot of things that I enjoy about being a teacher,” Mrozek said.
“Helping people understand things better, working as a team, organiz -
ing things, some of which are fun, some of which are serious.”
However, not everyone enjoyed camp growing up. Senior Maddy Hammett went to Sky Ranch, a camp in South Texas, for six or seven years for a week at a time. She stopped going to camp sometime when she was in middle school.
“I hated the heat [and] there’s a lot of outdoor activities [and I’m] not a very outdoorsy person,” Hammett said. “They made us do a lot of sports-related things [and] I’ve always hated sports and running, like exerting myself. I don’t like strict schedules and I had that too.”
Regardless of whether or not McKee’s guests enjoyed camp as a kid, her family and friends got to experience a weekend at camp during her wedding weekend at Waldemar. Her friends and family enjoyed taking a break from their devices and work and experienced camp activities.
“At the time, my now husband and I were looking for a destination that was within Texas and accessible for friends and family, but also somewhere that was increasingly meaningful and an added bonus full of natural beauty,” McKee said. “For a lot of our peers who are young professionals, getting to take a break from the busyness of life and work and get to just be outside and especially having both of our respective family members and friends really get to know each other through similar to camp shared activities like a kickball game, and just getting to enjoy being in the outdoors, go on walks or hikes, or do archery, things like that.”
S tory by Charlotte Tomlin Sports Editor
DJs taking selfies with guests, lights illuminating the dance floor, sequins scattered around the venue… one of the biggest celebrations of the year. Parties on a large scale, with a DJ, invitations and large venues tend to happen later in life, with weddings and milestone birthday parties. But for many seniors, their first largescale celebration comes with a graduation party.
In Texas, on average, it costs around $1,147.61 to throw a graduation party for 60 people, according to financebuzz.com. However, these costs can become exorbitant at ESD, as groups of students come together to celebrate, often inviting 200 or more people. These parties, with groups of around 15 to 20 students throwing a party together, can total up to $45,000.
“I’m just looking forward to having fun with my friends and being able to celebrate us finally graduating,” senior Lyles Etcheverry said. “It seems like it’s been a long time coming, but now that it’s here, it’s even more exciting. I am just excited to go to other grad parties and have fun with my class.”
Seniors typically invite their whole grade to their grad parties, along with juniors and seniors from other schools. Underclassmen tend to be left off the invite list, save for family members and a few exceptions.
“If it is a sibling or a very close friend then it’s okay,” Etcheverry said. “Other than that, grad parties are very overwhelming and are really for the seniors to celebrate their graduation. With too many underclassmen, I think parents worry more about control and something happening to the younger kids.”
Parents take a large lead in planning their kids’ grad parties. The theme and attire are usually left up to the kids to decide, whereas the parents are left to handle logistics.
“The kids had a meeting one night and debated for about an hour on the theme, title, and things we wanted to have at our grad party,” senior Jack Massey said. “Pretty much all of the logistical work (invites, venue, DJ, decorations, etc.) fell on the parents. They had a parent meeting and created groups responsible for different areas.”
The theme is arguably the most important part of the grad party. It sets the tone for the night and determines what the guests and graduates will wear.
Etcheverry’s grad party theme is Masquerade, whereas Massey’s is Disco. Deciding on the theme can be stressful as groups try to please every member, sometimes escalating into arguments.
“The most fun part [of planning] was arguing about the theme,” Massey said. “People were yelling and laughing, and it was really funny. My initial idea was Candyland theme, like the board game, but that was shot down. Most of the guys wanted a James Bond theme and most of the girls wanted a Disco theme, so we had to side with the girls.”
during the planning of his party.
“The venue was a massive pain,” Casey said. “I originally wanted to book a club for our venue because we would save money on decorations and lighting. The first club we tried to book said no because we were under 21, so we told the next one that it was a college graduation party, but somehow they found out it was a high school thing and also denied us. We ended up just booking a common wedding venue. Another challenging part was the DJ, [as] we wanted a young EDM DJ but one of the moms decided it wouldn’t be a good idea to spend our entire DJ budget on a DJ without confirming with everyone else first. That was very frustrating because everyone was texting me complaining about it.”

Other headaches of grad planning emerge in deciding venues and picking DJs. Senior JP Casey, whose grad party theme is “Gradsters”— a playful take on the famed golf tournament in Augusta, GA — had difficulty securing a
Although lots of students celebrate their graduation with large grad parties with groups of friends, a lot of students will also choose to have a smaller graduation celebration with their closest friends. For lots of girls, their aunts and grandmothers and family friends will throw a grad lunch or dinner in their honor as a way to celebrate their loved one in an intimate setting.
“I am having a grad dinner combined with Marguerite Davis,
hosted by some of our close family friends’ moms,” Etcheverry said.
“These moms graciously offered to have our friends at Shinsei to celebrate Marguerite and I graduating, so that is essentially why I am having a dinner as well as a party with my friends. At the grad party, more outside of ESD kids are invited as this dinner is mainly for my close friends at ESD.”
Even though large grad parties are not just an ESD phenomenon, the environment of grad parties differs from school to school across the metroplex.
“I think ESD parties are smaller than other schools because we don’t have as many kids,” Etcheverry said. “We don’t need to have a huge venue to fit everyone. I’ve only experienced a few other school grad parties, and they were bigger than the ESD ones I’ve attended in the past.”
Not to mention, despite some groups having a co-ed grad party, the celebrations tend to differ between all girl groups and all guy groups.
“Guys don’t really have grad dinners or lunches; that’s more of a girl thing,” Casey said. “[As for the big grad parties], I’ve noticed that the girl grad parties are always way more boujee than the boy ones.”
All in all, graduates relish the opportunity to be able to celebrate their accomplishments with their friends and family with good music, good costumes and a good time.
“I am excited for everyone to be together and celebrate each other,” Massey said. “This year has been a total blast, and to celebrate this amazing year with a huge party. I’ve also requested ‘Sweet Caroline’ to be played in honor of ESD Baseball’s 6-4 win over St. Marks. It’s the perfect way to combine the best sport with the greatest song ever created. I cannot wait to celebrate.”






















After six years of being together, Taylor Swift and Joe Alwyn suddenly broke up at the end of March. This news broke in early April when a source close to the couple confirmed the split with People Magazine. The anonymous source said that the breakup was a result of Swift’s and Alwyn’s “differences in their personalities.” It was also said that they grew apart and Alwyn struggled with Swift’s fame and attention. On May 5, Swift announced that the re-recording of her “Speak Now (Taylor’s Version)” album will be released on July 7.
Photos by Marcus Yam/Los Angeles Times/TNS, Allen J. Schaben/Los Angeles Times/TNS



Colonoscopies. Endoscopies. Patient consultations and data. Senior Neel Mallipeddi has seen it all. Through summer internships, he, along with 535 other students like him, may have seen a glimpse of their professional future, and they have the Eastin Family WORX Internship Program to thank for the experience.
The ESD WORX Internship Program started in 2014 as a way to give rising seniors an opportunity to be an intern at a company that corresponds with what they might be interested in. In 2021, Joe and Monica Eastin, parents of Kate ’24, Alex ’26 and Nick ’29, looking for ways to contribute to the school, funded this program because they thought it had a lot of potential to make a difference.
“I love seeing young people have new experiences,” Joe Eastin said. “If there’s an interest, and they can go and participate and flush it out, and see if that’s what they really want to do in life, because if we can give help give clarity early, then that that makes me very happy and what they want to do for their goals and career goals.”
Katherine Montgomery ’10, the Eastin Family WORX Internship Program coordinator, said that 90 current juniors will participate in the program this summer.
The 2023 Annual Met Gala was held on May 1 in New York City. The theme,‘“Karl Lagerfeld: A Line of Beauty,” was in honor of the famous German fashion designer who worked for many top fashion brands, including Chanel. The event hosted around 400 guests who wore elaborate and unique outfits. Some celebrities such as Doja Cat, Jared Leto, and Lil Nas X dressed up as cats to honor Lagerfeld’s cat, Choupette, to whom he left $13 million when he

by Francois Durand/
The 2023 Writers Guild of America is currently on strike. The writers said that it is getting harder for them to make a living with the current wages. This strike has caused delays in filming fan-favorite shows, such as “Stranger Things.” The directors of the show announced that it is not possible to film during the ongoing strike. The last writers strike occurred in 2007-2008 and lasted 100 days.
“We have a long-standing relationship with a lot of returning WORX employers who might have started as parents and are now alumni parents,” Montgomery said. “My favorite thing is that now we have former WORX interns who are employers and interviewers, and that’s really cool.”
Every student who completes the application process for a WORX internship is guaranteed placement. The application requires the submission of a one-page resume in addition to a “dream job” description. Then, each junior signs up for a 30 minute interview over Zoom, with 20 minutes of questions and 10 minutes of feedback. After a while, juniors receive an email matching them with their internships. The majority of the internships are unpaid and focus on the experience rather than the income.
“I’m really excited when I hear about a student’s experience,” Montgomery said. “[The internship could] change, maybe what they ended up majoring in, or they [can] write their essay about it, or they can get a rec letter from their employer, [stories] like that brings me so much joy.”
Dr. Megan Wood, an orthopedic hand surgeon at the Texas Hand and Arm Center, has been a WORX Partner with ESD for 10 years. Each year, she has two or three interns from the program.
“I usually host one at a time, and they just spend a whole week with me following me in the clinic, which is usu-

ally about two and a half days of clinic a week,” Wood said. “Then two days of just observing surgeries that need to go into the [operating room] and put scrubs on and all that.”
Wood believes that a successful intern is somebody who communicates, shows up on time and has a good attitude.
“You’re not really expected to know much,” Wood said. “Just have a pretty good attitude, be enjoyable and be open.”
Senior Blake Scheinberg interned for Wood last summer, shadowed her while diagnosing patients and watched her do several surgeries.
“This prepared me for the future because I plan to be a surgeon in private practice,” Scheinberg said. “Shadowing Dr. Wood allowed me to get a glimpse of what it is really like.”
The WORX program tries to recruit all types of businesses or organizations to try to match students with something they might already have a passion for. Junior Charlotte Tomlin, who is interested in sports journalism and broadcasting, will intern with the Dallas Mavericks this summer.
“The sports management experience interning with the Mavericks is perfect for me,” Tomlin said. “I am thrilled that the WORX program paired me with the Mavericks, and I absolutely cannot wait to start.”
Junior Wheeler Wood’s upcoming internship this summer will also help him with his summer job. In addition to his WORX internship, he will also serve at his dad’s restaurant, Jose, in Bluffview.
“I’m doing an internship at Nick and Sam’s for about a week for my WORX program,” Wood said. “I want to learn more about the hospitality industry and figure out if that’s an industry I want to pursue.”
Some internships are more than a summer job and can encourage students to think deeper and be creative and innovative. For Mallipeddi, who interned with Dr. Michael Weisberg through the Digestive Health Associates of Texas last summer, that was the case.
“I was inspired to start a personal project of my own that aims to use machine learning to diagnose polyps in the colon,” Mallipeddi said. “The project has been really fun to work on so far and increased my interest in using technology in medicine.”
The WORX program is an opportunity for students to pursue their interests but, just as importantly, discover that they might not want to pursue that particular career after interning.
“I’ve had, in 10 years, a bunch of [student interns], and I actually have a few students that made their way to med school and are doing great,” Wood said. “And then, I’ve had a lot of people who’ve spent their week with me and said, ‘That’s great. I don’t ever want to do this again. Thank you so much for saving the years of my life.’”

ucation. She is also interning with the United Nations International Children’s Emergency Fund, an organization that helps to improve the lives of children across the globe.
“I’ve always been involved in community service,” Ajith said. “I
ming for all members. Their mission is to inspire and support ethical leadership.” Krieser and her friends will work with wildlife and the environment. “When we are there, we are going to be working with turtles and doing a bunch of conservation stuff on the beach and doing turtle treks,” Krieser said. “We are also going to do rainforest station stuff.” Freshman Arya Ajith is also traveling with SStS for about three weeks to work in Kenya. The program she will be involved with focuses on community empowerment and children’s ed-
annual celebration, Coffee House,
to
the 42 edition of the award winning magazine
Teachers and students showcase their stories, poems, films, art
S tory by Beau McKnight, Lyla Zicarelli and Margot Cathey staff writers
The smell of fresh ink and paper is not the first thing that comes to mind when one hears the word Coffee House.
Yet, the aroma of the newly printed pages of this year’s Itinerary permeated the air of the Frank building on a recent Sunday afternoon.
This year’s Coffee House took place on April 30 at 6 p.m. in the Bray Theater. The idea of the annual event is to recreate the scene and match the aesthetic of an actual coffee shop or café. Copies of this year’s Itinerary, which is ESD’s award winning and nationally recognized literary art magazine, were set out on tables outside of the theater for attendees to take.
Heather Cernoch, English teacher and Itinerary advisor, along with each year’s Itinerary communication editors, organize the event, which she has been doing for the past seven years.
“The first purpose is to celebrate [the debut of the new magazine,] because the magazine is kept under wraps until Coffee House,” Cernoch said. “The second reason why we have it is to celebrate the creativity and artistic talent at ESD.”
However, Coffee House has not always been such a well attended, community event. Greg Randall, a recently retired English teacher, attended the first Coffee House which took place by the quarry in 1982. He made an impact on both the event and many of the student contributors.
For the first Coffee Houses, the Itinerary staff brought coffee mugs and cups from home, giving a warm and welcoming atmosphere.
“The whole upper school, much smaller at that time, gathered outside on the grass where the West Wing is now to receive their magazines,” Randall said. “Students volunteered to stand and read their work.”
Although Itinerary is now advised by Cernoch, the event is completely student produced.
“I just make sure they don’t set the building on fire,” Cernoch said. She essentially gives the students
the creative freedom to do whatever they envisioned. As co-heads of communications, senior Elisabeth Siegel and junior Kathryn Bakewell planned the event which displayed the paintings, drawings and photographs featured in this year’s Itinerary. The girls also made sure that the setting for the event and catering were in place. The event started in the atrium outside the Bray where coffee and pastries were served. At around 6 p.m. the crowd made their way into the theater and took their seats.
“The most rewarding part of planning a coffee house is actually seeing everybody at the event,” Bakewell said. “A lot of the stuff we do is preliminary work and we don’t get to see it till the day of. So once everything comes together and people show up it is really exciting.”
Senior Liam Pham and junior Charles Liu co-hosted the event and were in charge of introducing the students and faculty as they presented. They were humorous and kept the audience entertained. Each poem had a corresponding piece of art that was projected onto the screen and added a visual aspect to the writing that was being read.
“
purpose was to, “Remind readers that creating literature and art can be a tangible and physical experience that allows us to rise above our intellectual boundaries.”
Itinerary primarily meets as a club and has about 10 to 15 students depending on the year. For the past two years, Itinerary has also been offered as a class called Magazine. The staff receives over 100 submissions from students in grades nine through 12 as well as from faculty. As a team, the Itinerary members’ job is to sort through and select the best pieces and organize them into a common theme. Last year’s magazine won the Columbia Scholastic Press Association prestigious Gold Crown Award.
The most rewarding part of planning a coffee house is actually seeing everybody at the event. A lot of the stuff we do is preliminary work and we don’t get to see it till the day of. So once everything comes together and people show up it is really exciting.”
Kathryn Bakewell junior and Itinerary Head of Communication
“Hosting is a lot more spontaneous and happens on the day of the event,” Pham said. “Our job is really just to tie things together but also break up a lot of the serious atmosphere that often comes from the works being read.”
Coffee House is the culmination of months of work where every year Itinerary is unveiled. The magazine’s goal, as stated in the statement of p.12-13

EXPRESSION
LEFT: Senior Edie Dahlander shares her original song “Golden Hour” at Coffee House on April 30. “This was my first time playing an original song in front of a crowd - it felt great to share a part of me that hasn’t been showcased before,” Dahlander said.
RIGHT: Senior Reid Ackerman reads his short story “Weightlessness in Atlanta.” “I think it’s really cool that we can showcase our art at this school like this and would definitely encourage others to participate in the future,” Ackerman said. Photos by Lyla Zicarelli
This year, English teacher Erin Keller contributed a poem called “Barefoot.”
The poem was written as an interpretation of love and loss, but could also mean whatever the audience wants to depict it as and apply to their own experiences. Keller tries to fit as much feeling into as little words as possible in her writing.
“It was a privilege to be asked to read one of my little pieces and stand with the brave students who are courageous enough to share their gifts.” Keller said.
Student-produced films were also a large part of the event. The audience viewed a series of genres that ranged from love stories to amusing comedies. Freshman Elle Williams and seniors Reid Ackerman and Edie Dahlander presented their original short-films. Each film featured student actors and actresses.
Dahlander created the short film
“Norman” as a dedication to her graduating class of 2023. The film was produced, written and acted by the senior class.
Dahlander contributed multiple writings and films. This was her second year submitting work and she showcased an original song she wrote her sophomore year called “Golden Hour.” Although this piece was written three years ago, Dahlander has been working on more songs since then, but has not shared them.
The meaning behind the lyrics was to capture the “feeling [of] time slip through my fingers and not wanting moments to end,” Dahlander said.
Ackerman’s short film was a romance, and to him, the most special of all his works. He spent more than 100 hours on this film, and his work resulted in his acceptance to New York University, where he plans to continue to pursue his love for film production.
“My short film was the most special to me because I had been working on it for so long,” Ackerman said. “And the story is something I strongly connect with on a personal level.” Senior Sophia Ukeni was this year’s Itinerary editor-in-chief. She read her poem, “Room to Grow.”
“Writing, especially poetry, is a way for me to expand on my experiences in a creative way, and to inspire others to do the same.” Ukeni said.
Once all of the student contributors finished presenting their works, Cernoch honored junior Logan Betts who died at the end of April and had submitted photography pieces to Itinerary. His pieces this year included “Natural Connections,” “Window Into Isolation II” and “Addicted for a Reason.” All his photos were focused on nature.
At the end of the event, Cernoch also honored all of the seniors who dedicated a lot of time to the magazine during their senior year.
“Itinerary attracts the most creative, hard-working, responsible, motivated students on this campus,and the seniors are always leading by example, so when they leave we feel the loss, but we have some amazing students coming up to step into their shoes,” Cernoch said.


Our first stop was Bowlski’s Lakewood Theatre on 1825 Abrams Pkwy, Dallas, a bowling alley that was originally an old movie theater that was built in 1938 and then renovated in 2018 after a couple of years of vacancy. If you’re looking for some Friday night fun, it’s definitely worth going. The bowling alley also has a restaurant and live music that gives the atmosphere a vintage and 80s vibe. Although it was a bit pricey —$16 per adult for an hour of


If you’re looking for unusual, vintage and retro items ranging from clothes to jewelry, to other gadgets, East Dallas Vintage on 1327 N. Peak St., Dallas is the place to go. They recently expanded their store so it now covers two shop fronts. They have little nooks with paintings, chairs and lamps, and other sections of the stores are dedicated to jewelry or clothing. Their new edition had more luxury items like expensive jewelry and fancy utensils. The store had a warm feel to it, and it reminded me of my grandmother. Each item seemed to have its own story. If you’re looking for a new and different place to shop as I was, you have to pay them a visit, you won’t


FRIENDS, STUDENTS AND TEACHERS SHARE MEMORIES OF THOSE THE ESD COMMUNITY LOST THIS SCHOOL YEAR
Izzy Martin came into my English class quietly, time knowing her would I categorize her as ‘quiet.’ she’d laugh at the first sentence of this piece and on my word choice.
In fact, she was one of the coolest sixth graders was wicked smart, stubborn, strong-willed, sassy, honest, even when it wasn’t convenient for her being honest, she made her own curriculum and bent to her will without much effort on her part. challenged her and wrote compelling arguments be read by others. After class, I’d wheel her to lunch and we’d have little chats on the way, and got to hear her hot take on the world. She was grade team often laughed and smiled thinking of lives. She passed away this summer after battling
What’s important is that Izzy didn’t leave quietly; such a sound that we can’t ignore her time here remains a force of conviction in our community. generosity, and justice has created a climate of I know she would have wanted nothing less from Izzy feels impossible; she was a force of nature, memory as a bright, golden light. Above all, Izzy daughter, and was a student in our classes, here brought so much light and warmth into our lives.
Hannah Bowick Middle and Upper School English teacher
When I met Izzy in early August of 2020 of my was a new student that had moved from Christ as I started to get to know her, I instantly knew friends. She was diagnosed with cancer in the started that year. While she was dancing, she broke doctors found cancer in her bone. This was just started school with us at ESD. As a new student, on Zoom classes from the hospital and because I could spend time with her. She affected the world
During her hard times, she would volunteer for charities, even in her wheelchair or on crutches. of person that would never think of herself but help others. It wasn’t just her actions but also her an impact on many. Izzy was so funny and she on everything. If she didn’t want to listen to the If she didn’t want to play a certain game, she would playing it. She always wanted to do it herself, and anything. When she would get up with her crutches, to assist because she was perfectly fine doing
One of the many things I liked about her was she had in God at all times. No matter what happened, God was on her side. She was also the smartest couldn’t go to school because of treatment, that get ahead on all the work we had for the whole when I FaceTimed her to ask for some help on already done the worksheets for the next couple one time when our advisory had to come up with Halloween and we decided that everyone would onesie. On the day we dressed up, Izzy was on that didn’t stop her from wearing her onesie with more people could have gotten to know the one because she really was one heck of a person. McCall Moore ‘28
Izzy loved school and loved to learn, and I was Izzy as her sixth grade math teacher. Izzy excelled challenged herself intellectually, even though her teachers learned so much more from her. She was much as physically possible, would attend classes never use her diagnosis, treatment, or pain as an kept up with the material, and despite missing consistently score one of the highest grades on a great sense of humor and didn’t hold back from and opinions.
Mrs. Infante and I were sore from working out pushed Izzy in her wheelchair to chapel, and she so hard with her witty comments about our soreness comments about teachers’ wheelchair driving skills of her classmates rallied behind her, and we all we wore Team Izzy shirts and made a paper chain memories, stories, or words of encouragement a Google Meet LunchBunch with Izzy once a week, attend a few of these in person as well. She had giving heart and was dedicated to giving back she could so other kids didn’t have to experience she endured. Her family, the love they have for in God is also incredibly strong.
Izzy’s family refers to her as a force, and that beautiful sunset, I think of Izzy. When I see a happy Izzy. When I ask someone for a book recommendation, When I wear yellow or blue, I think of Izzy. She difference in the lives of others through The Team her love is continuously spread. Thank you, Martin Izzy with us at ESD. We are better and forever changed known her and having her in our lives.
Allison Darnell Assistant Head of Middle School

quietly, but at no point in my ‘quiet.’ If she were here, and tell me I need to work graders I’ve ever known. She sassy, and honest. Always to be so candid. If we’re and I mostly followed along, She read books that arguments for why they should the dining commons for and this is usually where I beloved, and our sixthof her presence in our battling osteosarcoma.
quietly; Izzy Martin left with here with us. Izzy’s presence community. Her heart for service, action and purpose, and from all of us. Memorializing nature, and she exists in my Izzy is a friend, a sister, a here on this campus, who lives.
my fifth grade year, she the King to ESD. As soon we were going to be February before school broke her femur and just a few months before she student, she would usually be because she was in my advisory, world with her actions. for all different kinds of crutches. She was always the kind about ways that she could her personality that made always had an opinion song, she would skip it. would tell you we were not and never needed help on crutches, she didn’t want you it by herself. was the amount of faith happened, she knew that smartest person I knew. If she that wasn’t an excuse not to month. There were times homework and she had couple of weeks. I remember with a costume idea for would be a different animal Zoom in the hospital but with everyone else. I wish one and only Izzy Martin
was blessed to know excelled in her classes and her classmates and was present for school as classes remotely, and would an excuse. She always some lessons, she would on assessments. Izzy had from sharing her thoughts
out one morning as we she had us laughing soreness as well as her skills or lack thereof. All showed our support as chain that classmates wrote on for Izzy. The girls had week, and Izzy was able to had such a kind, caring, and to others and doing all experience the pain and struggles each other, and their trust that she is! When I see a happy sunflower, I think of recommendation, I think of Izzy. continues to make a Team Izzy Foundation, and Martin Family, for sharing changed from having

I met Logan a couple of days into fifth grade since he was the only other one crazy enough to get to school at 7 a.m. Seeing that our only other company, until more students arrived, was each other, we quickly became friends. Immediately upon arrival, we would both go grab a delicious Sage breakfast and sit down. He would complain about his morning rowing practice, and I would follow by complaining that my breakfast taco lacked bacon. This process repeated all throughout middle school and even into high school.
I have so many good memories, but perhaps one of my favorites would be at the Oklahoma Invitational race this year. It started off the same as any other race. I would wake up at 6 a.m. for the departure time of 6:30 a.m. and he would wake up at 6:25 a.m. Upon arrival at the lake, he immediately needed to take out his one-person boat, which I carried oars for, and get ready to race. Right as he was about to send off to race, I shouted some encouraging words to hype him up, closing off my chants with, “Make sure not to flip,” which he promptly did as soon as I turned my back. Right before his race, he and the inside of his boat were now covered with lake water. Rather than complaining about how cold he was, he persevered forward and finished the race.
Hours later, it was time for our doubles race. He was undoubtedly sore from his race prior to ours, but that didn’t matter to him. We went out onto the water praying that we could beat the other boats, with teams we’ve never heard of. Luckily, our prayers were answered and, after a grueling 2,000 meters race, we got off of the water having won the whole race. We promptly got second in our next race with two other people, thus closing our day off with a successful series of races. Logan was a great rower and an even greater friend who I will never forget. Cole Spence ‘24
Fun-loving. Curious. Creative. Multi-talented. Great sense of humor.
“Can we have nap time today Mr. Warner?”
One of the things I will most remember about Logan was his innate ability to see the beauty in his surroundings and be so curious about the science in those same surroundings. It often takes me a year to get most students to the point where they will do this and yet Logan came into my class with that gift already in him.
It wasn’t long before Logan’s love of photography sparked his curiosity about chemistry and his wheels started turning. By mid-October he started staying after class a couple of times a week or stopping by before school to chat about chemistry and picking my brain for ideas (I didn’t realize at the time that was what he was doing). I figured it out when one day he casually asked me if I knew anything about the chemistry of photography. Little did I know by saying “yes, I have had a number of students over the years do photography projects” that I would be on the hook for another photography project.
But this was different- nothing I had tried before.
“I got this idea for putting photographs on different surfaces like cloth and metal. What do you think?” he said.
“Uh, ok. Do you have a clue how to do that?” said the experienced chemist.
“Ya, I want to make a silver halide gelatin emulsion,” Logan said. “And I want to learn how to make it stick to a piece of metal, like copper. What do you think?”
“Well, Logan, there is good news and there is bad news. The good news is I know how to make an emulsion; I know how to make gelatin, and I know how to make a silver halide solution. The bad news is I don’t know how to do all of that at once and I sure don’t know how to get it to stick to copper” I said. “Can you do some research and find other photographers or chemists that have done this in the lab before?”
“Yes sir! I will get back to you as soon as I can.”
The next day he sent me the research he had done with a note respectfully cajoling me to look at it as soon as I could because he was really excited to get started. I reviewed it, realized we would need to order some special chemicals and other materials and asked him if he was serious about completing this as I would be happy to order the stuff if I could trust he was planning to follow through. He assured me he was and made good on his promise by coming in every week to keep the ball rolling on the project. Our last meeting was two days before his death.
I lost much more than an AP chemistry student when he passed away. I lost one of the most interesting, curious budding chemists I have ever had the honor of spending time with.
I will miss him terribly. I am grateful for the time I got to spend with him and will treasure memories like these of this wonderful young man.
Walter Warner Upper School Chemistry teacher
Logan Betts, a quiet leader among us, exemplifies the word “commitment” in every aspect of his life. Commitment is defined as dedication to something or someone and Logan without a doubt was dedicated to his family, friends, crew team, photography, and his desire to give back to the community. In every aspect of his life, he personified goodness and his desire to make the world a better place.
As long as I can remember, I have known Logan and there are some unique and inspiring qualities about him that make me proud to call him my friend. First, Logan loved people and made everyone feel better about themselves. There isn’t a person who has anything bad to say about Logan, can we all say that? Second, as a peacemaker in a world that is fueled by conflict, people like Logan are a rare find. When we were younger, Logan was always the first to try and mend any spats our friends might have. Even at a young age, he valued people and friendships and realized that “we are stronger together.” Finally, his compassion for his community and the world was exceptional and for many of us, it inspired us to get involved and give back.
His time spent at Family Gateway was a true gift to the organization and families he served. Logan didn’t volunteer for any other reason than it gave him a sense of fulfillment to improve the lives of others. At the annual Christmas event, Logan photographed the kids with Santa and without a doubt, his remarkable patience with kids and his ability to connect with everyone around him is beyond aspirational.
Like everyone, it saddens me to be praising Logan for just some of the amazing things he did in his short life, and I wish that I had said these things to him when given the opportunity. I think Logan would want us all to know that life is hard for everyone, and we should all try to lift each other up. In the end a life well lived is leaving the world a little better than when you came into it. So Logan, you lived a good life
1981-2023
I remember walking out of D period math everyday in seventh grade excited because my favorite class, E period English with Mr. Smith was next.
Mr. Smith was a very special teacher that was passionate about teaching, poetry and debate. Everyday when we walked into class, we could expect Mr. Smith to be sitting at his desk next to the window sipping a cup of tea. In the hallways we would always see Mr. Smith dressed in his usual wardrobe choice of a dark collared shirt and comfy dark bottoms. Although later on we discovered Mr. Smith had been struggling with health problems, during his class and teachings he never let these struggles show.
Mr. Smith also had some of the most entertaining stories– from when he faked being a doctor for his friend who lied about a sick grandma, to his eye-catching first car. Mr. Smith was also an amazing Youth and Government advisor. Although we couldn’t find common ground in our thoughts about paper straws, he always encouraged every delegate to express their ideas. Mr. Smith always encouraged us to express our beliefs through daily journal entries, and we even almost had a debate unit.
Mr. Smith was an amazing teacher who impacted many students, including me. Before I had Mr. Smith, I never thought I was good at English and didn’t have a lot of confidence in my writing abilities. Mr. Smith inspired me to discover my potential in English and made me gain confidence in my writing skills. He was a teacher that had a huge impact on our ESD community and inspired many students in his short time at ESD. You can tell Mr. Smith was a beloved member of our community by the vast attendance at his memorial service, his Go Fund Me which has raised more than $32,000, and the fact that the MS girl’s lacrosse team dedicated one of our games to Mr. Smith. Almost everyone at the game had TS, his initials, drawn on our faces and legs using eye black.
Mr. Smith, we miss you a lot and thank you for everything.
Wendy Chen ‘27
Just imagine: a teenage Trumaine Smith, driving home from school with an enormous smile on his face, listening to Tupac in his new car and getting home in time to watch “Saved by the Bell.” Later, he would go to Red Lobster with his family, making sure to avoid all the slimy seafood like oysters, going for something more like fried shrimp instead. These were just a few of the memories he shared with me in the nearly two years I spent learning from him. Simple conversations with him always came easily as he was an incredibly interesting person. We were completely different people with completely different backgrounds, but we always found ways to bond. Our admiration for rap from the 2000s, movies and our shared revulsion for particular “cuisines” was something we could bond over for hours on end. Those conversations with him were so comforting to me.
I was always so happy when I walked into E Period English in the morning and saw Mr. Smith sitting at his desk, sipping tea in the dark by the window, with a journal prompt on the board, and I know I’m not the only person who felt this way.
Mr. Smith had an incredible impact on every single one of his students. Everybody loved him, as he never failed to bring smiles and laughs to our faces through his sarcastic and playful remarks. He was outstanding at his job, pushing students, including myself, to carefully examine topics I had never considered. He pushed my writing to be deeper and more clear, taught me how to be direct with my points, and how to use English as my stage and microphone to reach people.
One of my favorite of the many ways that Mr. Smith kept all his students captivated and intrigued in his teachings, was the way he incorporated topics and current events that we, the students, saw in the world all around us. He saw this as a way to help us all discover our place in the world. He never taught from textbooks, but instead from the lessons that he knew were important for us to learn.
Another iconic Mr. Smith technique was to always use his dry and absolutely hilarious sense of humor to keep us on our toes. You never knew when you were going to be zapped by the Mr. Smith sword of sarcasm. He never used his humor to stab anybody but he wasn’t afraid to give them a friendly poke.
Trumaine Smith truly had a profound impact on me, and so many other students. We did not get nearly enough time with him, but he was still so loved and will be loved and missed forever. Thank you.
Emory Turner ‘28
In the late summer of 2021, Mr. Smith applied for an English teaching position at The Episcopal School of Dallas (at the urging of his wife, he told us). When he met with us that August, we knew immediately that we had in our midst a man with a gentle, giant heart–the perfect person to guide, mentor and love students in our community. Mr. Smith connected with every child he encountered, both in the classroom and on the football field. He made students and athletes feel seen and heard. He made them feel like they and their efforts mattered. Being a middle school student can be difficult at times, but Mr. Smith was there for every child on this path, helping them find their way with faith and confidence. He was a gift to all in our community, and we will carry his spirit with us in the days and years to come.
Tolly Salz English Department Chair
Recent losses prompt the community to gather, remember, take action
S tory by Abby Baughman and Easterly Yeaman Co Editors-in-Chief
After the recent loss of two beloved community members, junior Logan Betts on April 5, and seventh grade English teacher and football coach
Trumaine Smith on April 8, the ESD community has come together to support each other in our time of grief. The administration worked with school counselors Merredith Stuelpe and Amanda Sherman to put together a plan in order to best support students as they came back to school.
Upper school students gathered in the chapel the morning of Thursday, April 6 when Head of School David Baad announced Logan’s death. After the announcement, members of the junior class sat in the quarry throughout the day because it was Logan’s favorite place on campus. Students also bought flowers and placed them by the quarry and under his photography work displayed in the Frank Building.
“Everyone was together, but not exactly,” junior Charlie Massoud said. “The quarry is a big open area, and it was Logan’s favorite spot so I figured it would be the best place for everyone to go if they wanted to be together.”
Later on Thursday, Baad communicated through email that students and their families were welcome to gather in the chapel from 5 to 6 p.m.
“Mr. Baad thought it was really important because when Logan’s death was announced, it was in the chapel, and people were really shocked and taken off guard,” Stuelpe said. “They really thought it was important to bring everybody back together in the chapel in a way that felt like they were providing structure to how everybody was grieving and coping and to sort of help people connect with each other in a way that was special.”
Junior Will Grogan and his friends brought candles for students to light and send out onto the quarry’s waters after the service. Students also placed candles around the flowers that had previously been
laid out on the rocks in front of the quarry.
“I took my friends Tripp and Harry to Target and we bought 400 candles and some glue, and we went to Brooks’s and they had bought all this wood then we glued them on,” Grogan said. “We thought it’d be a nice touch to honor Logan.”
The response was a natural way for students to come together and support one another. When grieving, it’s common for people to take action.
“I think when people are grieving, they really are searching for something to do to make it more real because people are just shocked,” Stuelpe said. “The idea of coming together and having a ritual that memorialized Logan by putting the candles in the quarry, I think that was just a natural thing that organically happened and that wasn’t guided by any of the administration, but it was just another way to show how much the students care.”
Logan’s closest friends and family posted tributes on Instagram that received hundreds supportive comments and reposts from other students and friends of Logan. These tributes included pictures of Logan throughout his life along with captions sharing how Logan positively impacted their lives.
“I wanted to dedicate something to him since it was in my photography account,” Massoud said. “We shared a love for photography and were gonna go to AP together, so I mainly just wanted to make something to bring attention to his work and who he was so people could look into that.”
The following long weekend, Baad sent an email to parents notifying them of seventh grade English teacher Trumaine Smith’s death.
In the email, Baad re-emphasized the importance of supporting one another by reaching out during dif -

“I think when people are grieving, they really are searching for something to do to make it more real because people are just shocked.”
Merredith Stuelpe upper school counselor
ficult times.
“I hope that all of you were able to enjoy a peaceful long weekend with loved ones,” Baad said in his email to parents about returning to school Tuesday. “The past several days have brought significant heartache to our community with the deaths of junior Logan Betts and seventh grade English teacher Mr. Trumaine Smith.”
The administration knew that returning to school the following Tuesday would be a challenge for students, so they implemented multiple measures to make sure students were supported. Teachers were asked to use their own judgment to decide whether or not to continue class as normal.
The seventh-grade students returning to school had the opportunity to write letters to the Smith family. They were told to share funny memories or positive experiences with Mr. Smith.
“The way we phrased it to them, which I think was meaningful, was explaining that you saw Mr. Smith in a context that his family didn’t have access to,” middle school counselor Maricela Aquino said. “His wife doesn’t work here and his kids don’t go here. So being able to share funny memories or how Mr. Smith was for you as a teacher, is like giving them a glimpse of someone that they love in a way that, like, they don’t have access to. Like you guys are giving them that gift.”
On April 15, Lauren Swann parent of ‘29, ‘27 and ‘24 started a GoFundMe page dedicated to supporting the Smith family during a difficult time.
“This community loved Mr. Smith,” Swann said. “Each and every one of his students respected him greatly and each had a unique connection with him. He knew how to reach his students. I know
IN MEMORIAM
LEFT: Juniors William Lett, Xavier Monteiro and Will Grogan light candles on the dock at the quarry on April 6. “We wanted to do something special in the moment that people would remember,” Grogan said.
Photo by Charlie Massoud LEFT: Class of 2024 moms gathered on April 10 to wrap white ribbons around the trees on campus as a sign of support for the community.
“Logan was an amazing friend and teammate of mine, so I wanted to honor his legacy in any and every way could,” junior Ben Guerriero said. “I helped the moms of our grade put up white ribbons on nearly all trees on campus with several other classmates to honor Logan and Mr. Smith.”
Photo by Abby Baughman
our community wanted to honor him and let his family know how much he meant to us all and how much we loved him. Everyone was asking, ‘How can we help them?’ We thought that the GoFundMe would be helpful to his family and a way for the ESD families, friends, faculty and staff to support them.”
Only a few hours after the GoFundMe was started, the $15,000 goal was surpassed. Currently, ESD community members and friends of the Smith family have raised $32,000.
“I know that [donating to the Smith family] was also something that adults in the community like teachers were very interested in,” Aquino said. “There are several adults within the community saying making the cards and donating DoorDash or similar gift cards is all great and lovely, but the reality is he was in the hospital for multiple weeks and I’m sure that’s going to add up, so they [wanted to help the family] in a little bit more tangible way. So that was really amazing and wonderful just to see a very tangible way of measuring just the power of support that that ESD has.”
The counselors especially want to emphasize the importance of reaching out for help when needed. ESD has many resources other than counselors, including teachers, advisors and other trusted adults who care deeply about students.
“The counselors are always available,” Stuelpe said. “We have a student wellness group that is open to all upper school students. If somebody needs help or needs support, it’s so important for them to reach out. There’s a lot of resources here whether it’s Fr. Nate or it’s an advisor, or it’s the dean or whoever they feel most comfortable with. Finding an adult to talk to is really important.”
If you or someone you know is in crisis, contact the Suicide and Crisis Center of North Texas Hotline: (214)-828-1000

COTTON CANDY SHAVED ICE
Although not an exclusively snow cone restaurant, the iconic Chip’s on Lovers Lane offers a wide variety of snow cone options at their bar. On a hot Saturday afternoon, I decided to grab lunch at the classic, bright yellow burger joint. After eating lunch, I ordered a cotton candy snow cone, which cost $2.50, and received it in less than a minute. They had a menu of about 15 standard flavor options, including cherry, blue raspberry and cotton candy, and they only offered one size that was comparable to the Bahama Buck’s small size. Though sitting on their patio on a sunny day with a cold dessert is half of the experience, the snow cone fell short in many aspects. The shaved ice did not replicate “snow,” as the chunks of ice were too large. Additionally, there was not nearly enough syrup to saturate the snow cone, so it felt like I was just eating ice. Compared to other snow cone shops, the price was worth it for the size of the snow cone. While Chip’s has a nice ambiance and great food, the snow cone was nothing special.
4530 W Lovers Lane, Dallas





After a confusing 20 minutes switching through highways, I drove up to the bright lights of Snow City Café. The café is beautifully designed and has plenty of seating. Bingsoo, an interesting Korean milk-based take on snow cones, was delicious and I have never had a dessert quite like it. The portions are huge and come with an ample amount of toppings. I got the mango shaved ice, and the ice was super fluffy. The toppings are also dispersed throughout the snow cone, so get some mango in each bite. My shaved ice was about $12, but it is definitely meant to be shared, definitely enough for two to three people. I think Snow City Café is worth the drive because the strip mall it is located in has loads of restaurants with dishes not traditionally offered in Dallas. For example, there is a Korean BBQ restaurant and a Korean corn dog place, so if you drive up there you can definitely spend a few hours there. Additionally, there are a myriad of options if you don’t like snow cones like Nutella stuffed pastries.
2540 Old Denton Rd #130, Carrollton
p.17-21
new theme parks will bring to the Dallas metroplex
Every ESD Upper School student has felt the stress of the Wednesday schedule. Legs bounce nervously in the chapel pew as they feel minutes ticking by, wondering when Father Nate will proclaim, “Let us go forth in peace to love and serve the Lord,” and the exodus to the Dining Commons will start. Students stress about the lack of time they have for lunch, as four grades must move through lunch lines in quick succession in order to allow students enough time to eat.
Oftentimes, students are left scrambling with not enough time to eat a good lunch. Thus, the Eagle Edition staff believes that the upper school should return to the Wednesday schedule put in place during the second semester of last year when the class period after lunch started and ended 10 minutes later than it would on other weekdays. Those extra 10 minutes came from Big Flex, which was shortened to 20 minutes. This schedule allowed ample time for students to eat lunch and didn’t take away from class or Eucharist time. Students greatly appreciated the schedule change last year, as did teachers — so why was it ever taken away?
With the current schedule, students are allocated 30 minutes for eating from the time Eucharist is supposed to end, at 12:55 p.m. However, we all know that Eucharist typically ends at 1:00 p.m. or 1:05 p.m., leaving students about 20 minutes to get from chapel to the Swann Building, go through the lunch line, sit down, eat and find time to socialize with their
friends. For seniors, their advisory lunch time is shortened — one of the only times during the week when seniors see their advisory. Students are stressed as they try to manage the chaotic lunchroom environment, stress that is only amplified as the clock ticks closer toward 1:25 p.m., signaling the end of lunch. By adjusting the schedule to allow 10 extra minutes for lunch, students would be on time for class (decreasing CVs that result from being tardy), have enough time to eat a nutritious lunch and have decreased stress levels as they transition to the second half of their day.
The Center for Disease Control recommends that students have 20 minutes of “sit down” time for eating, which is time spent after getting their food that the student uses to socialize and eat. This time can be achieved with a 30-minute lunch period, which is the CDC’s recommendation for schools. More time for lunch also has health benefits. According to the CDC, studies have shown that more time for lunch leads to increased consumption of food and key nutrients, increased selection of fruit, increased consumption of fruits and vegetables and decreased plate waste. Additionally, according to Mayo
“By adjusting the schedule to allow 10 extra minutes for lunch, students would be on time for class (decreasing CVs that result from being tardy), have enough time to eat a nutritious lunch and have decreased stress levels as they transition to the second half of their day.”
Clinic, 15 minutes is not enough time for students to properly digest their food, and most children in the U.S. get 30 to 50 percent of their daily calories from their school lunch meal. And the American Academy of Pediatrics recommends that “students be given enough time to eat their school lunch because they are more likely to enjoy their food and eat healthier options when they are not rushed.”
Not to mention, the physical act of eating healthier foods (whole grain, leafy vegetables, and fruit) takes longer because of the time required to peel or chew tough textures. Lack of time to eat means lack of nutrients. Thus, if students do not have ample time to eat and make healthy choices regarding lunch, it can affect their health and well-being.
Also, many students find themselves buying snacks from the Eagles’ Nest as a substitute for the lack of time in the lunchroom. As a consequence, students are not consuming a well-balanced and nutritious meal that they could be eating if they had a normal amount of time. Adjusting the schedule would allow for students to be able to eat a well-rounded meal that they would otherwise be missing on Wednesdays.
Furthermore, lunchtime isn’t just essential for physical health, but mental health as well. Lunch
allows time for socializing that high school students desperately need to help ease stress and build community. Also, a 2016 study from the Journal of the Academy of Nutrition and Dietetics showed that breaks in the day help improve cognitive functioning, boosting students’ moods and increasing their motivation. Allowing just an extra 10 minutes in the lunch period would help boost ESD upper school students’ moods — and discourage them from complaining about the lack of lunchtime they are given on Wednesdays.
According to Assistant Head of Upper School Jeff Laba, the decision to not continue the Wednesday schedule put in place last year was made in hopes that everyone would be able to make it through the lunch lines in sufficient time. Thus, the extra time was not necessary for just one day a week. However, students disagree with this decision: in a May 10 poll of 78 students, 93 percent of respondents said they believe that the schedule should be modified to allow for more lunch time on Wednesdays.
For the upcoming school year, ESD should make a special Wednesday schedule similar to the one they put in place last year: shaving off 10 minutes of flex time and adding it to the lunch period, so that the period after lunch starts at 1:40 p.m. and lasts until 2:40 p.m., with Big Flex lasting from 2:40 p.m. to 3:05 p.m. In this optimal schedule, Eucharist is not cut short, the lunch period is extended to allow students enough time to eat, and class time remains the same.
ESD students and teachers alike will be happier, and stress will be eased with the implementation of this new schedule.

S tory by Elisabeth Siegel staff writer
Around 90,000 to 120,000 years ago, humans started wearing animal furs and hides to cover and protect themselves from low temperatures. According to a study by the iScience journal, researchers unearthed 62 prehistoric bone tools used to process animal skins. Kings used these skins to display their power, and hunters used them to give them strength.
In the early 20th century, animal patterns adorned the fashion scene in Hollywood. But now, because of activist organizations like People for the Ethical Treatment of Animals, more people are opposing the use of animals as clothing pieces. Times have changed, and animals should not suffer anymore for the production of fashion.
Although people have been wearing clothes made from animal furs and hides for thousands of years, the meaning behind and purpose of these garments have changed. In modern society, there are so many alternatives to animal skins; wearing animals is no longer used for necessity or tradition; it is used as a fashion statement. Wool, fur and leather can be made of synthetic fabrics like acrylic plastic fibers, wax and polyester that mimic the natural feel of these materials. Second hand or vintage pieces are also a great option if you want the same “real” feel. Many vintage boutiques and markets have a decent range of preloved fur coats, woolen sweat-
ers, and leather jackets. Contemporary society is no longer made up of Neanderthals who need to use skins for warmth; we now have a plethora of tools and machinery that eradicate our need for animals for survival.
Fashion is responsible for the unnecessary trapping, farming and skinning of billions of animals each year. According to the Food and Agriculture Organization of the United Nations, 2.29 billion cows, calves, buffaloes, goats and pigs were killed to make leather in 2018. More than 95 percent of wool comes from global mass production, where animals such as goats, sheep, rabbits and more are subjected to painful treatments and dangerous substances. According to the Fur Commission, United States mink farms, where animals are electrocuted and skinned, produce around 3.1 million pelts annually. Down feather, feathers plucked from ducks, geese and swans, is prized by the fashion industry for its ability to protect against the cold. Most down is obtained by a painful process of live-plucking.
“Although people have been wearing clothes made from animals
for
thousands of years, the meaning behind and purpose of these garments have changed.”
Elisabeth Siegel staff writer
However, not all use of animals for clothing is cruel. Many indige -
by Sarah Cabrales
nous peoples use animal furs and skins as clothing out of necessity or culture, which may seem cruel to many vegan activists. However, when these tribes hunt the animals, they make sure to never waste any part of the animal and only take what they need for survival from their environment. Fashion designers from these tribes use their collections to bring the designs of their ancestors to light and to reclaim their heritage. Asking indigenous peoples to give up the traditional hunting methods that they have been using for centuries will only end up isolating indigenous culture, especially since the practice is deeply rooted in tradition and respect. Instead of targeting the indigenous, the change must start within today’s fashion industry. Yes, people of all backgrounds have historically worn animal products. However, starting in the mid-20th century, the practice of wearing the garments transitioned to a luxurious fashion statement instead, significant for culture or survival. Many alternatives give off the same amount of warmth and style as the real material from animals. If the suffering of animals is unnecessary, let’s do everything we can to avoid the atrocity of our fellow living beings.


Former Co-Editors-in-Chief
Grace Worsham and Maddy Hammett reflect on their time spent with the newspaper from 2020-2023 and how they learned to be grateful for all the experiences
We have procrastinated writing this, maybe because when we finish it our time with the paper will really be over or simply because of our worsening senioritis (though Maddy’s has been prominent all year). Writing this last letter from the editors, while experiencing many other lasts these past few weeks, makes everything feel so final. It makes it hard to enjoy what little time we have left.
“Poems, Prayers & Promises,” a song by John Denver, reflects on growing older—a song we believed was fitting for our current positions. Denver sings, “I’ve been lately thinking about my life’s time, all the things I’ve done and how it’s been. I know I’m gonna hate to see it end.”
It is bittersweet to say the least. Walking down the same halls we have become so accustomed to and talking to the people we have spent the better half of our lives with makes it feel as though we are leaving a part of ourselves here when we go. Yet, we are about to encounter a new, enticing chapter of our lives in new places with new people. We will once again be freshmen in a new environment and community.
The song later goes on to say “For though my life’s been
good to me there’s still so much to do, so many things my mind’s never known.” Although we have formed memories and friendships that will last a lifetime, and have ourselves become so close to each other, we have so many more memories to create. We have so many more places and things to experience, people to meet and thoughts to share, but it’s scary. It has been a difficult thing for both of us, admitting when there has been something we did not know. It is one of the most fundamental parts of growing older.
Ultimately, more than anything, we are grateful. Grateful to be the voice of such a unique student body, grateful to have the opportunity to report on what we feel is important, and most importantly, grateful for our time spent with one another. Denver writes “It’s really fine to have the chance to hang around.” Though it would be impressive to say that all of our time spent in newspaper was directed toward our work, a good majority of the time was spent laughing with each other, bonding with staff members, making inside jokes, eating bagels on Sunday workday mornings, making an Abby-lee inspired newspaper pyramid and, of course, spending way too much time on letters from the editors as senioritis began to kick in.

Looking out into the quarry each day from the window near our computers, listening to folk music and hearing the drumming of fingers hitting keyboards has been a comfort to us for the past four years. The past year, we’ve found ourselves at an impasse. It has been difficult to look forward while there has been so much keeping us rooted. It has been difficult to find times to be thankful when so much of what we’ve been doing has focused on the future. For the class below us, instead of telling you to cheer louder, score higher or run faster, we simply tell you all to give your -
“Looking out into the quarry each day from the window near our computers, listening to folk music and hearing the drumming of fingers hitting keyboards has been a comfort to us for the past four years.”
selves grace and be thankful. The beginning of senior year is chaotic and stressful. If we were to speak to ourselves nine months ago we would ask ourselves only this. Especially with the difficulty this last year provided you all with. We can’t provide you with a clear silver lining, but know that with the coming year, there is still time to become even closer
Thank you ESD for letting us, just like Denver, “Talk of poems and prayers and promises and things that we believe in” and finding out how “sweet it is to love someone, how right it is to care.”


Twenty-two million tourists flock to Florida’s Universal Orlando Resort annually, embracing the chaotic vacation hotspot with open arms. In the upcoming years, the Dallas metroplex can expect a similar environment because Universal Parks announced on Jan. 11 a new theme park coming to Frisco in the summer of 2026. This 97-acre project will be accompanied by the Merlin Productions Peppa Pig Theme Park and Dude Perfect World, coming to the metroplex shortly thereafter. While the introduction of these theme parks is exciting, Dallas will be reinvented as an amusement park destination, discarding its historical and cultural attractions; traffic will also increase with the inevitable onslaught of visitors.
The traditional image of the Dallas metroplex includes the downtown skyline, the stockyards, the Dallas Museum of Art or the Texas State Fair. But with the introduction of the Florida theme parks, America’s perception of Dallas will shift to “the site of Universal Parks.” Historical attractions will suffer in the shadow of Universal Parks, contributing to the dissipation of Dallas culture. Inevitably,
the nostalgic Six Flags of Texas, founded in the 1990s, will decline in popularity as the brandnew parks gain traction.
Overcrowding is also a serious issue, as theme park developers will gradually gobble up land in the suburbs and rural areas surrounding Dallas. Open land will be replaced with new buildings and infrastructure; farms or ranches surrounding Dallas will shrink as our city expands with new projects. Obviously, traffic will boom in the Dallas metroplex, hindering everyday work commutes and contributing to air pollution. Universal Parks expects 7,500 visitors each weekday and up to 20,000 visitors on weekends or holidays. Further, the park will be located near the Dallas North Tollway, a mere 30 minutes away from Dallas proper, promising frequent traffic on this highway and the surrounding area. Traffic issues are already prevalent in Orlando, which is ranked fourth in traffic conditions in the U.S. The swell in traffic will undoubtedly boost air pollution in the Dallas metroplex, a current pressing issue. The American Lung Association already graded Dallas, Denton, Tarrant and Collin counties’ ozone pollution
“The onslaught of theme parks in the Dallas metroplex will have a negative impact on our Texan culture and create traffic concerns because Dallas will become merely a ‘theme park destination.’”
Charlotte Traylor
as an “F,” according to ABC News. Ozone is derived from emissions from burned fossil fuels, namely the gasses that exit a car’s tailpipe, and can interfere with vegetation growth or act as a greenhouse gas. So, the influx of traffic will only add to Dallas’s environmental degradation and poor air quality.
Aside from the consequences in Dallas, many questions have arisen regarding the success of this trio of theme parks, specifically concerning the targeted audience. Universal Parks has announced that their new park is geared toward a younger audience than their other parks.
“[The park] is scaled smaller to be more intimate and engaging for younger guests,” Frank Heinz said in an NBC article published on Jan. 11. “The company said the theme park will have a completely different look, feel, and scale compared to Universal’s existing parks.”
Dude Perfect World is a theme park based on the Dude Perfect sports YouTube channel. Its following primarily consists of lower or middle school boys, while Peppa Pig’s demographic is toddlers and young children. There is value in children’s entertainment, but creating an experience geared towards all ages
would generate greater profit.
According to the Dallas Morning News, members of the Frisco City Council were concerned with Universal Park’s intended audience, because “a park that specifically targets young children will likely not survive in the long run.”
The introduction of theme parks will boost the economy in Dallas, as new job opportunities will arise, hotels will receive more business and travel to Dallas will increase. However, this must be considered within the context of Dallas’s current economic state. Dallas has a booming economy, in no desperate need of new theme parks to reinvigorate economic growth. According to the Texas Employment Forecast, 2.8 percent job growth is expected in the metroplex in 2023, without any stimulus from the amusement park industry.
The onslaught of theme parks in the Dallas metroplex will have a negative impact on our Texan culture and create traffic concerns because Dallas will become merely a “theme park destination.” As Universal Corporations and Merlin Entertainments make a home in Dallas, the city we know may gradually slip away.
Dear Editors,
I read with great interest the story in the most recent edition of the Eagle Edition titled “Is Your Fake Your Friend” and regarding fake identification cards being procured and used by students. In the article, the authors mention the consequences for using such an item would be considered a class B misdemeanor. I write to comment that there are more serious charges associated with such an offense, and I worry that our students may not be aware.
It is important to define that an ID card or driver’s license is considered a government document and if someone presents a fake ID that looks like or attempts to mimic a real Texas ID or DL when being asked to verify their age, that person is purporting that card to be the real thing. There are occasions when use of such an item is considered a felony and could have long lasting consequences to the person in possession of the card.
The Texas Penal Code Section 32.51 covers Fraudulent Use or Possession of Identifying information. While the spirit of this particular law is to create a consequence for those who engage in identity theft, this law is written that any government issued identification number is considered identifying information and the use or possession of someone else’s government issued number constitutes a state jail felony as long as the actor has fewer than 5 items in their possession. Many of the fake IDs I have seen have someone else’s ID or DL number listed as the official number of the license. This is enough to meet the criteria for the offense. Texas Penal Code 37.10 covers Tampering with a Governmental Record.

TUnder this law there are many items that are covered but the use or possession of a fake ID that was used with the intent to defraud or harm another makes the offense a state jail felony. Using a fake ID to purchase alcohol from a store or bartender when the seller could be charged with a crime for selling to an underage person is enough to constitute the intent to defraud or harm.
A felony conviction is life altering.
Having a felony on one’s record can affect college scholarships, the ability to live in an apartment or rent a home, vote, own firearms, work in certain businesses or industries, hold public office, etc.
I appreciate the opportunity to share this important information with your readers.
Jody Trumble Director of Campus Security
he Parental Rights in Education law was signed into law by Florida Governor Ron DeSantis on March 28, 2022. Most people are more familiar with it by the title of the “Don’t Say Gay” bill. The goal of this law is “to reinforce the fundamental right of parents to make decisions regarding the upbringing and control of their children in a specified manner,” which sounds completely reasonable. However, many critics are furious with the specific section in the bill stating that “classroom instruction by school personnel or third parties on sexual orientation or gender identity may not occur in kindergarten through grade 3 or in a manner that is not age appropriate or developmentally appropriate for students in accordance with state standards.”
Now, DeSantis wants to expand the ban on sexual orientation or gender identity from grades fourth through 12th, unless required by existing state standards or as part of reproductive health instruction that students can choose not to take. I believe this law has good and clear intentions of giving back the rights
to parents of knowing the curriculum and mental health of their child.
To millions of parents, this bill no doubt sounds noncontroversial. Their children’s mental health and school records are eminently their business. Parents have a right to ensure that the curriculum is age-appropriate and that it is focused on learning instead of promoting someone’s cultural agenda. The bill lets them vindicate parental authority — a major factor when creating this bill. Parents should be the first to introduce topics about sex, puberty and other related topics. Kindergartners are supposed to be learning how to read and peaceably resolve turf wars over toy trucks or who gets a turn on the swing. To their ears, “sexual orientation” is a string of silly nonsense syllables, and they shouldn’t be learning such topics when they’re that young. It’s not only confusing but unnecessary to 3, 4 and 5-year-olds.
From a Tampa Bay Times article in 2022, after the first version of the bill was signed, it was unclear exactly how things would change in the classroom because sexual orientation and gender identity are not something that is being taught in grades K through third. I find
Dear Editors,
Six years ago, The Eagle Edition wrote a brief story about me and my impending arrival at ESD. Since that time, I have developed a close relationship with ESD’s student newspaper. At the start of every year, I sit with the entire staff for a “press conference” which covers a number of topics on student minds. For almost every edition, I have sat for interviews, reviewed articles and eagerly devoured the final product. I have thoroughly enjoyed getting to know many staff members of the EE over the years, as we have worked together on a variety of pieces about life at the school, in the Dallas community and around the world.
Most of the readership, however, does not know of my deep relationship with the EE editors. Weeks prior to every issue, they make an appointment with me to discuss articles the paper plans to publish for the upcoming issue. In the process, they have to endure my questions, my suggestions and my bad jokes. They have defended their staff, pushed hard to have their voices heard and maybe, just maybe, downplayed a few controversial stories.
I will miss these conversations greatly and appreciate them all.
To Julia, Kathleen, Anastasia, Madison, Emily, Victoria, Evelyn, Blair, Emily, Gina, Maddy and Grace, thank you for the laughs. Thank you for your wisdom. Thank you for your patience and grace. Most of all, thank you for sharing a part of yourselves with me and greatly enriching my experience here at ESD. I can’t imagine a better student newspaper.
Henry Heil Head of Upper School
B y Alexandra Warner staff writer
it interesting that critics of the bill get so riled up about subjects that aren’t taught in elementary school in the first place.
One of the many worries about this bill is that teachers may be fired and sued if any discussion over sexual orientation or gender identity is brought up, like conversations by students over families and assignments given like drawing a family tree. However, lawmakers have explained that those lesson plans would still be allowed if the assignments prompt a discussion about a student’s LGBTQ+ family member. In a nutshell, lawmakers say classroom discussions led by students on those subjects will not be impacted through high school.
Another major argument made by critics is that the bill tries to ban talking about LGBTQ+ history and gender, but the document doesn’t even state the words gay or LGBTQ+.
A quote from a CNN article stated that “educators who never mention the existence of trans people or important milestones in LGBTQ history are indoctrinating students by those omissions to believe that those identities are shameful, and that queer people deserve to live in the shadows.” I completely dis -
agree with this statement. It’s 2023. There is nothing to be ashamed of and if anything, I believe we are an extremely accepting society.
Another significant section of the bill is the mental health aspect of the child. In a parent-child relationship, confiding in one another is crucial to maintaining a strong and healthy relationship. And if a child doesn’t reveal the issues they’ve been facing at school whether it’s bullying or struggling with school work, there’s no way a parent would know what their child is feeling. However, this bill would provide the school administration the ability to inform parents of any mental health issues, a right that should have already been given to parents.
I understand that people may be upset with the expansion of the bill for the many different reasons previously stated; however, again, this law was proposed to give back parental knowledge of curriculum and mental health. Parents should have the right to know if this curriculum includes sexual and gender orientation, because they have a right to know their child’s education which is the whole point of the bill in the first place.


By Anoushka
As the world faces an increasing urgency to address climate change, the debate over renewable energy versus traditional fossil fuels continues to rage on. Many countries are striving to reduce their reliance on the use of fossil fuels and their effect on climate change. The Willow Project, set to take place in the North Slope of Alaska, is one that aims to advance the development of clean energy for the United States and reduce our reliance on foreign energy production. There is no doubt that this project may be causing great harm to the issue of climate change, but it definitely has many more positive impacts on the economy than portrayed online and on social media. The Willow Project provides many benefits that could advance and transform the future of our energy landscape, and it is estimated that at its peak, the project will produce around 180,000 barrels of oil per day.
This new Alaskan source of oil guarantees that the U.S. has a domestic and more dependable supply of energy. As of 2021, according to the U.S. Energy Information Administration, Saudi Arabia and Russia made up 13 percent of the total petroleum imports and are two of the top five sources of petroleum and crude oil. Additionally, as of a few years ago, Venezuela was a major contributor to the petroleum industry of the United States. All three of these countries have considerable political issues or relationships with the U.S.
After the recent invasion of Ukraine by Russia, it is imperative that we rethink our relationships with these countries. Similarly, the association the U.S. has with Saudi Arabia is solely based on oil, while their government is a monarchy that restricts many political rights to their citizens and even more restrictions to visitors. While we no longer get as much oil from Venezuela as we did in previous years, there is exceptional political corruption and their method of energy production is arguably very polluting. There will always be a possibility that we will have to go back and ask them for more oil, but having the production from the Willow Project will decrease the chances that we have to go to them again. Having a domestic source that produces a significant amount of oil for the country is a very valuable resource instead of relying on foreign countries. The real question is, do we really want to have to rely on these types of countries for our major energy production when we can have a dependable and domestic source of energy?
The Willow Project also provides Alaskans with an opportunity to strengthen the struggling economy of their state. According to the University of Alaska Center for Economic Development, from 2015 to 2021, the Alaskan economy performed “at or near the bottom” nationally in four key measures of economic health which are employment growth, unemployment rates, gross domestic product and net migration. Alaskan Representative and the first native to the state elected to Congress Mary Peltola said that, “The Alaska economy has no growth. We’re not in a slump. We’re not in a ditch. We’re in a crevasse. And it doesn’t seem like there’s any upswing.”
She argued that the Willow Project would provide key jobs and increased revenue to alter the economic state of Alaska in hopes to raise their national standings of economic health. According to ConocoPhillips, the largest oil producer in Alaska and also the creator of the project, the Willow Project will provide Alaskans with around 2,500 construction jobs and 300 permanent jobs.
Additionally, the project provides Alaska with a source of income for the region to fund key services such as healthcare and public education. According to the Alaska Policy Forum, students in Alaska have placed at or near the bottom consistently when evaluated through standardized testing for years. This proves that the education system in Alaska is greatly lacking and something needs to be done to make these numbers go up. On top of that, teachers are also asking for additional funding and a more defined-benefit plan for retirement. According to the U.S. Department of the Interior Bureau of Land Management, Willow could produce $8 billion to $17 billion in revenue. Previously, in 2019 the Alaskan oil and gas industry contributed $3.1 billion to the state public safety and education according to the Alaska Oil and Gas Association.
The Willow Project presents an opportunity for the United States to advance the development of clean energy and reduce dependence on foreign oil sources. While the project may have negative impacts on the environment, it has the potential to provide numerous benefits to the economy and the people of Alaska. Therefore, it is crucial to approach this issue with a balanced perspective and to consider the potential positive impacts of the Willow Project. As a society, we must strive to find a balance between economic development and environmental preservation and take decisive action to secure a sustainable future for generations to come.

We have a major problem with the direction our planet is headed in. Our planet is paying the price of our actions. We have been destroying and neglecting Earth for many years and if we don’t take action immediately we will no longer have a habitable planet to live on. Climate change has become a controversial and heavily talked about issue in the 21st century. This century’s politics has become a focus in American society, with climate change often being politicized. Red states such as Texas have been benefiting from this industry for many years. According to the American Oil & Gas Historical Society, oil has been a major part of the Texas economy since 1866. The state of Alaska, in contrast, has only been in the oil drilling scene since 1967.
For 44 years, the government has leased Alaskan land to major oil companies such as Hilcorp Alaska LLC, Aix Energy LLC and Alaska Development Company. The Willow Project is a government initiative to add more oil drills in the North Slope of Alaska. According to CNN, the project passed because it will create new jobs, boost energy production and make the U.S. not reliant on foreign oil production. These oil companies are profiting while causing detrimental effects to people, animals and the environment in Alaska. This project is causing harm to so many different groups that we must do everything we can to put a stop to it before it is too late.
The Alaskan people’s health is suffering directly from the Willow Project. According to Inside Climate News, Rosemary Ahtuangaruak, who worked as a health aid in Nuiqsut, reported people being treated for respiratory disease more often when oil drills were in their town.
In addition to the declining air quality, the natural land of Alaska is also suffering. The native polar bears in Alaska are losing their habitats due to the Oil leakage that happens in their waters, which forces them to relocate to live on land with humans. Defenders of Wildlife, a U.S.-based national conservation organization, published that scientists are predicting that by 2040, over half of the polar bear population in Alaska will spend three to four months on land. But for them living on land is often their last resort as they need ice to survive. This change will make the bears spend more time near human activities and homes, resulting in more polar bears attacking humans.
Oil is not only harming animals that live permanently in Alaska, but it also harms wildlife that migrate through the area. The National Ocean Service, America’s coastal and ocean agency, claims that oil destroys and reduces mammals’ ability to warm themselves and harms birds’ feathers, making them vulnerable to the cold and less water repellent. It exposes these animals to harsh environments they are not used to. Without the ability to repel water and insulate from the cold water, birds and mammals will die from hypothermia.
There has also been an increase in toxic algal blooms; these are caused by an overgrowth of algae that bonds with chemicals. Algal blooms produce harmful toxins that affect humans, fish, marine mammals and birds. The United States Environmental Protection Agency says that the oil industry is a major source of methane emissions. Methane is a greenhouse gas that has the potential to warm the earth 25 times more than carbon dioxide. The algal blooms can produce Methane. The drilling also creates chemicals that contribute to the formation of ground-level ozone. The EPA also stated that ozone exposure can cause a multitude of health issues, such as aggravated asthma, increased emergency room visits, hospital admissions and premature death.
All these problems will be intensified by the Willow Project. According to the Wilderness Society, a land rights activist group, the project would generate enough oil to release 9.2 million metric tons of carbon pollution a year. This pollution will warm the planet, contributing to longterm shifts in temperature and weather patterns, also known as climate change.
On March 13, the Willow Project was approved by the Biden administration despite protests and pressure from the public not to go forth with it. Over 1 million letters were written in protest to the White House.
It is our duty as humans and Americans to protect our Earth for future generations to come. We often take for granted our planet and all it provides us. We must do everything in our power as citizens to put a stop to this destruction. Actions you can take are to be mindful about who you are voting for, sign petitions to show your support, and to be involved in numerous organizations that help combat this issue. No money or jobs that come out of this will be good if we do not even have a planet to live on.
S tory by Charlotte Traylor News Editor
ESD students packed the stands on March 31 for the home ESD vs. Jesuit boys lacrosse game, excited for their notorious rivalry. But during the game, several students were called down from the stands.
The smell of alcohol wavered amongst the crowds as eager students shouted in the bleachers. Three seniors received suspensions after admitting they had consumed alcohol. In turn, the majority of the student body disappeared, along with much of the support for the ESD lacrosse team.
“[The atmosphere] was like any other student section before, but then everyone started getting [called down by Mr. Heil] and leaving after that, so it was under ten upper schoolers and a handful of middle schoolers [and parents],”
junior Margaret Shirey who attended the game said. “No one was even sitting in the bleachers, everyone was just sitting against the rails; we were trying to bring the energy to support our team, but it was nothing like a full crowd.”
Even though the Eagles bested the Rangers in a 11-6 win with few student fans, it is undisputed that fan energy is a necessity in sports sections, as reminders to attend the game were sent on GroupMe throughout the week.
“[The absence of fans] held a major effect on the lacrosse team’s fan base and the players,” senior Ryan Turner* said. “At ESD lacrosse is one of our biggest sports and our team relies on a student section to keep everyone motivated. With a
game like Jesuit, the crowds battle to get into the other team’s head. It’s just the way it is and it’s part of the game. Without a student section, our team is put at a disadvantage.”
Although the attendance at lacrosse games is usually less than those at football games, students still enjoy the spring Friday night lights. The absence of so many fans from the student section was abnormal, and Head of Upper School Henry Heil was disappointed in students’ inability to support lacrosse for the entire game.
“It was really unfortunate that all the students left, presumably because they were also under the influence,” Heil said. “That means that there was no one there to cheer for the lacrosse team, and that’s what is a real bummer because their poor decisions [limited] the support that [the team] deserved.”
“A pretty large group of students showed up and were shouting inappropriate things at the other team which worried me,” Heil said. “[Also] I could smell alcohol. I didn’t know where it was coming from, but I could smell it.”
Heil felt the March 31 game was rowdier than a typical game, contrary to student opinion.
“[The atmosphere] was like any other student section before, but then everyone started getting [called down] and leaving after that, so it was under ten upper schoolers and a handful of middle schoolers.”
Margaret Shirey junior
After observing the game environment, and the atypical student behavior, he concluded that the situation was a risk to the students, with his primary concerns being students’ safety and their representation of the school. In the heat of the situation, rumors of breathalyzing circulated. But in reality, Heil addressed the situation through conversations with students.
SEASON SUCCESS
Varsity lacrosse players celebrate during a March 25 home game against Westlake. Eagles won 9-6, adding to their season record.
“It was pretty typical —a normal game,” junior Morgan Amison said. “Actually, it was probably less rowdy than normal because we did not have a speaker.”
Sophomore lacrosse player James Altizer, who was on the field during the game, said the game felt like a normal game. “The game seemed to be just like the others,” Altizer said. “In comparison, Jesuit is always more rowdy than ESD.”
The situation prompted mixed results from the community, namely the student body. A senior student posted on Schoology after the game, referencing the “why are you no fun” (WAYNF) slogan.
“I do not think it was appropriate that I was called down by Mr. Heil,” Turner said. “I believe I was picked out because my behavior was just like everyone else or considerably better than everyone

else. His initial reasoning why he picked me was because he could smell me from the track. After speaking with him he changed that answer and said I was being unusually nice. I assume he changed his initial response after realizing it didn’t make sense that he smelt me from so far away and not any of the other kids shoulder to shoulder with me. I still am unclear as to why I was picked, as the other students picked were roughhousing.”
Some students respected the actions taken by the administration in order to provide a safe environment for the students.
“I understand the actions taken by the ESD administration at the lacrosse game,” lacrosse player Carson Davis* said. “However I also understand that ESD versus Jesuit is a big rivalry and a large crowd is a necessity. That being said, I don’t expect the administration to turn a blind eye towards underage drinking. Overall I believe ESD’s actions were appropriate.”
Even in the midst of student questions, Heil is confident in his handling of the situation and will remain committed to the school and his personal values.
“I understand the story that ‘the administration is out to get the kids’ is a much easier narrative, [but] I’ve got to be concerned about student safety,” Heil said. “So anybody who’s been drinking I want to make sure they get home safely. So when that happens, I call their parents and have the parents come pick them up safely. My goal is to have students be safe and be appropriate and represent the school well.”

percent
A
S
Jamie Henderson Arts Editor and Social Media Manager
Asking for help is common and encouraged at ESD, and the softball team is no different. When the team struggled to field a roster this season, girls in other sports and activities jumped in where they could — a prime example of the power of the ESD community.
Six players show up to every practice and game, making up the true softball team this year. But according to softball rules, each team requires nine players to start a game and only eight are needed to continue playing once the game has started. To complicate things further with the ESD team this year, one player, senior Camila Rivera, got hurt playing soccer and underwent surgery—she is now in recovery.
When coach Mike Schneider, who is the softball program director and upper school health and PE teacher, realized he would not have enough players to create a full team, he got creative and searched for girls who could potentially join the team on a part-time basis, even if they had never played softball before.
“The season has been challenging [so I] give a lot of credit to the six kids for hanging in there,” Schneider said. “And I have a lot of appreciation for the girls that have been subbing because we couldn’t have done it without them.”
Sophomore Katelyn Hurt played softball last year but switched to
lacrosse this year in order to better her goalie skills for field hockey, her main sport. Although Hurt’s main priority is lacrosse, her coach was willing to accommodate and allow Hurt to help the softball team for certain games. Other part-time players, like track and field member Madison McCloud, came from other spring sports, and some, like senior Edie Dahlander, did not play a sport this season.
“I have a lot of appreciation for the girls that have been subbing because we couldn’t have done it without them,” Schneider said.
The team only had to cancel one game because of a lack of players.
Schneider said that when coaching a varsity sport, it is always best to have players who have played before at any level.
“It becomes difficult when you basically have to start from scratch,” Schneider said. “However, the kids who haven’t played before have actually been great, so that has not been an issue.”
This year’s team consisted of one freshman, three sophomores, one junior and one senior. Last year’s team had 12 players and was made up of two seniors, three juniors, five sophomores and two
“ We are very closeknit because it is so small and [we are] very supportive of everyone.”
Taylor Turner junior
freshmen. Most of last year’s team was already fairly experienced and understood the sport, unlike this year’s team, which had many players new to the sport.
“Our team is considerably a new and young team, but I feel with Sarah [Cabrales’] and [my] guidance, we have been able to [create] better softball players,” junior and co-captain Taylor Turner said. “We are very close-knit because it is so small and [we are] very supportive of everyone.”
Not many girls in the upper school have played softball before, and it is a difficult sport for those new to it. So, finding people to sub in was difficult.
“Softball is a really, really difficult sport to play,” Schneider said. “I don’t think most people understand how difficult it is both physically and conceptually. So you know, it’s not quite as easy to just plug in missing pieces as it might be in other sports.”
Assistant softball coach and upper school acting teacher Lauren Redmond coached softball in middle school but had to stop because of scheduling conflicts between the two divisions. When the position became available for the varsity team this year, she was happy to help.

THIRD BASE THROWS
LEFT: Sophomore Jesi Geier plays third base at a home game against Hockaday on March 23. “The game against Hockaday was probably one of the most fun games,” Geier said. “It was great to see the girls who had never played before make good plays to get the Hockaday girl out.” RIGHT: On March 21, senior Sarah Cabrales pitches for the home game against Greenhill. “I’ve been pitching for the team since freshman year and I absolutely love being the captain of the team this year!” Cabrales said.
Photos by Lyle Hawkins
“Softball is a tough sport to learn but easy to enjoy,” Redmond said. “When you have a team that wants to play, that’s half the battle.”
Despite the small roster, the atmosphere of the dugout allowed for a dedicated team space. The dugout is usually filled with snacks, water and Gatorades for the team. The coaches play warm-up music and each player has a personal walkup song every time they go to bat. Some girls paint eye black on each other or themselves to get into the spirit, while others wear ESD softball visors during fielding. While the team hits, all the other members stand at the fence and cheer on the girl up to bat. The girls are constantly rooting for one another and giving positive feedback.
But Schneider and Redmond aren’t the only team coaches.
Assistant coach Jenny Latta’s love for the sport runs deep after playing it all her life and her daughter playing too.
“She fits in with the team perfectly, and she’s the most sweet and patient coach ever,” sophomore player Vivian Chen said.
One of the reasons the team has seen less players has to do with middle school not having a team, which is usually a feeder to the upper school team. Other contributors to numbers dropping this year include demanding class schedules, fine arts electives or extracurricular obligations.

S tory by Sophia Sardiña Life Editor
It was a challenging season. First, the team had 17 players last year and only 13 this year. Second, a few of these players were new to the game. And lastly, they struggled with strengthening the dynamic of the team and forming a roster. But even with these issues, the team managed to work through and overcome the challenges.
“Seniors leave every year obviously, but we had 6 seniors last year,” varsity baseball coach Gregg Bennis said. “And many of which were key contributors for the past three years.”
Because of this, newer players joined with little to no experience. Not only was this difficult for the rising freshmen, it was also hard on the current players as they had to teach and help the new team members.
“Because we lost six players, many players with little game experience are getting to start,” Bennis said. “With the lack of experience, it has taken some time for the new starters to get comfortable. They have really started to show signs of growth. We are in a better place now than we were in February which is promising.”
But even with the lack of players and lack of experience, the baseball team didn’t recruit any players. So, the team doesn’t have any substitutes, designated hitters or runners.
“Even though it’s hard to play with new players it’s fun to lead and teach them,” sophomore baseball player Johnny Willingham said. “It’s great helping them out
and playing with them.”
The baseball team has made this season more promising by having more ‘team moments’ and team bonding. Willingham has noticed a dynamic change from last year revolving around new efforts to unite and connect the team.
“It’s been easier this year to connect,” Willingham said. “We go to dinners after every game and make efforts to connect as a team as opposed to last year.”
In a similar fashion, coach Bennis has attempted to make the games and practices seemingly more inclusive with the student body as well as his players. This year, they added a new speaker system in which each player got to choose a walk up song along with music between innings.
“I chose ‘It’s a great day to be alive’ by Tavis Truth,” Willingham said. “It’s a great song because for one, I love country music, and I think that every day should be a great one.”
A big change from last year is the student body’s involvement. The baseball team passes out flyers, free concessions and bracelets. For the home opener of the season, the team passed out flyers promoting the game. Similarly they passed out bracelets.
“I think that the flyers and bracelets help promote the games,” Willingham said. “We got a bunch of fans out there to our first game, so we have hope for our closing ones.”
Social media has been key to promoting games. Frequent texts in the Horde GroupMe, the ESD Horde Instagram and the ESD baseball Instagram help encourage attendance to games.

“I think both Instagrams are great,” Willingham said. “They promote our games and I do think that it has made a difference in fans.”
. “I love baseball because it has been around my whole life,” Willingham said. “I started young because my dad was a coach, and then I just grew up with it.”
Photo by Kristin Doebele
Food is always a crowd pleaser. Another effort promoting fans to come watch has been the free concessions held at each home game.
“Unlike last year, we now have free concessions with hot dogs and treats,” Bennis said. “It’s one of the efforts to pull fans and I think it has worked out well.”
“They’re a great new feature and a good change” Willingham said. “They’re a lot more comfortable and they look a lot better” With new and continued attempts to unite the team, the dynamic underwent drastic changes, most for the better.
“What made this season a lot better was the team bonding,” Willingham said. “This year we play together and feel more like a family.”
The team changed the look of the new uniform. The maroon Eagle was added to the logo and the material is different than previous uniforms.
“Talent wins games, but teamwork and intelligence wins championships.” —Michael Jordan


play an important role in life, at every level
S tory by Callie Hawkins staff writer
For the past two years, I have written diligently as the sports editor, covering important issues within the sports world from college athletes getting paid for their image and likeness with the NIL rule to the effects of sports betting on younger generations. But I haven’t stressed enough about the impact of sports on my life and everyone else’s.
From the first time my dad placed a soccer ball at my feet at age two, sports have played a large role in my development as an athlete and also as a person. In middle school, I played six sports, before realizing in high school that two varsity sports were enough for me. As I prepare for the next stage of my life at the University of Texas, I know sports will continue to have an impact on my life.
There’s absolutely no doubt that sports are incredibly important for both physical and mental development. Playing sports helps individuals maintain good physical health and build muscles and cardiovascular strength. But off the field, sports also helps to develop important life skills like teamwork, leadership and discipline. Sports are proven to have a significant im-
pact on a person’s mental health and well-being. Playing sports can reduce stress, improve your mood and boost self-confidence—I personally can attest to this. Being part of a team, part of something bigger than just yourself, teaches humility, respect, integrity and mental strength.
It allows you to build another identity within yourself and make long-lasting friendships with teammates and coaches you might never have reached out to before. Even if you don’t play sports personally, you are still exposed to the ideals and lessons taught on the field by watching and hearing about them. This rings true especially growing up in Texas, where football is a religion and Friday Night Lights is every child’s (and parent’s) favorite show. Sadly, my time on the field ended my senior year. As I look back on my time as an Eagle, I will always be grateful for my experience playing sports,
“Being part of a team, part of something bigger than just yourself, teaches humility, respect, integrity and mental strength.”
Callie Hawkins
but I know that the impact of ESD sports on my life will not end when I walk across the stage at graduation. In college, sports ignite a sense of pride, identity and community within the environment of a university or college. Sports in college build school spirit and unity, create opportunities socially for all students and the student athletes, and foster a competitive environment. I personally am going to a school where sports are an integral part of what the university is known for. However, even if a school is not known for their athletic program, all schools have a competitive aspect in one way or another, whether it be within athletics, academics, arts, etc. Just like competition extends off of the field, my love for sports will continue for the rest of my life and the lessons I’ve learned from coaches and teammates will guide me as I grow older.
In the United States, no matter
who you are or what your interests might be,sports shape our culture. American football, an integral part of American culture, was invented in a schoolyard, when a student, William Ellis Webb picked up the ball during a football (soccer) game and began to run with it. The first official game was played in 1869, establishing it as our own unique sport and making it a part of what the United States is known for. Even if you personally don’t partake in watching football and other sports, think about the broader events in sports that the entire world is influenced by. The Olympics, the FIFA World Cup, the Tour de France… when those are happening, that is all anyone can talk about. People want to be part of it, to have pride and cheer for their country. Sports is the biggest passion I have had so far in my life and I have gotten to meld that with another passion of mine, journalism, through the position of sports editor and the writing of my column. No matter what your passions may be, whether it be sports, the arts or something else, there is no doubt that sports have an impact on everyone’s life, even just as a spectator. Sports can provide you with background entertainment, a reason to socialize, or may just change the direction of your life altogether.
When did you start playing tennis? Why?
I started playing tennis when I was about 4 or 5 years old because my parents signed me up for a summer camp. At that point, I was basically just trying every sport. I ended up loving it, and I kept wanting to go back, so eventually, I started playing more and more.
What has been your biggest challenge in tennis, and how have you overcome it?
My biggest challenge has been trying to play at a really competitive level (I mainly practice at Brookhollow, but I play matches and tournaments all over) while also managing schoolwork, friends and more. Tennis definitely takes a lot of time and effort, and learning how to manage that has been really difficult. I still struggle with getting everything done sometimes, but I think the biggest help was just learning how to manage my time appropriately and realize when I need to maybe skip practice one day or get homework done in advance so I can go play a tournament.
What do you love most about tennis and the ESD team?
The thing I love most about the ESD team is how supportive and nice everyone is. Tennis can be really hard because it’s typically an individual sport, so it can get kind of daunting and lonely sometimes. Being on a team, though, has made it so fun, and I love getting to feel like I’m playing for something more than just myself. All the people on the team are so fun to be around, and the whole atmosphere is just really happy. I also love how there are so many different components to tennis, including different shots, fitness and more. There is always something to improve on, and I really enjoy that.
What do you hope for the future of your tennis career and tennis team? Personally, I hope to play in college at some point. For my team, I hope we just continue to have fun, improve and win more matches!

Q1) A bug crawls along the x-y coordinate plane, starting at the origin (0,0). Each second, the bug can crawl 1 unit in the up, down, right, or left direction. What is the probability that after 10 seconds, the bug is at the position (5,5)?
SENIOR TOM QIU formulates complex mathematic equations for each issue. If you think you have found the solution please email a picture of your work to Qius@esdallas.org The first person who answers correctly will receive a prize. Good luck, it’s as easy as pi.

Web Editor Brooke Ebner
Q2) x-y=4, x3-y3=28. Find x2-y2
Q3) What is the unit digit of 781?
Social Media Manager
Jamie Henderson
Staff Writers Emma Allen , Valentia Boltchi, Katherine Bowden, Arden Bowen, Drew Dundon, Margot Cathey, Alex Eastin, Layna Girata, Jane Herburger, Beau McKnight, Emmy Moss, Ryann Parker, Maggie Pickens, Reese Rawson, Harper Sands, Ryder Sands, Ella Scarborough, Anoushka Sinha, Kate Smith, Lyla Zicarelli
Cartoonist Sarah Cabrales
Faculty Adviser Ana Rosenthal


10:00am-6:00pm
10:00am-5:00pm

































Recognizing the Class of 2023’s college commitments






























Reid Ackerman | New York University
Kate Battaglia | Wesleyan University
Will Benners | Southern Methodist University
Jackson Bloomfield | Oberlin College and Conservatory
Elise Bostian | Texas State University
Jett Bowling | Texas A&M University






















Cren Boyd | Howard University
Blair Brennan | Washington & Lee University
Briggs Briner | University of Texas at Austin
Mackenzie Brooks | University of Tennessee, Spain
Billy Bryan | Austin College
Beatrice Bryan | The City College of New York
Patrick Burke | University of Texas at Austin
Truth Byars | Southern Methodist University
Sarah Cabrales | Abertay University Dundee
John Cahoon | University of Texas at Austin
Andrew Carrie | Auburn University JP Casey | Southern Methodist University
Drew Chairuangdej | Wheaton College
Chase Chazanow | University of Arizona
Sanders Chipman | Chapman University
Michael Cohen | University of Texas at Austin
Russell Coleman | Austin Community College District
Fia Collins | Texas Christian University
Jack Crofford | Auburn University
Edie Dahlander | Undecided
Marguerite Davis | University of Alabama
Cole Defeo | Northwestern University
Victor DeMedeiros | Texas Christian University
Olivia DeYoung | Wake Forest University
Amber Donahue | University of Tennessee, Knoxville
Katye Dullye | University of the South: Sewanee
*Garrison Elliott | The University of North Georgia
Lyles Etcheverry | University of Tennessee, Knoxville
Kensley Ewing | Texas A&M University
*Grace Exall | William & Mary College
Parker Forde | Auburn University
*Dagen Geier | Undecided
Elizabeth Goelzer | Texas Christian University
Sophie Goelzer | Texas Christian University
Alexa Grabow | Texas Christian University
Reagan Grady | The United States Naval Academy
Camille Gravel | University of Texas at Austin
Henry Hamlin | University of Virginia
Madeline Hammett | New York University
*Raafae Haq | Undecided
Mia Harrington | University of Miami
Callie Hawkins | University of Texas at Austin
Katherine Hess | Southern Methodist University
Bryce Hill | Southern Methodist University
Ava Hobbs | Texas Christian University








202 colleges and universities applied to 435 acceptances to 143 colleges and universities $10,810,436 in




Asher Hoodis | Austin Community College District
Mary Cate Houk | University of Texas at Austin
Hunter Hurt | Boston Conservatory at Berklee
*Maxim Jovanovic | Penn State University
Jake Kelton | Belmont University
Emma Konen | University of Arizona
Camryn Kowalewski | American University
Quaid Kozelsky | Belmont University
Corbin Lane | University of Oklahoma
Jack Lattimore | Eckerd College
Ogden Lindh | Southern Methodist University
Neel Mallipeddi | Rice University
Zach Manna | Indiana University Bloomington
Jack Massey | Wake Forest University
Hood Mathes | University of Georgia
Elliott McCabe | University of North Carolina
Madison McCloud | University of Texas, Arlington
Justin McCray | East Central University
Grace Meaux | Auburn University
Katherine Mote | Stanford University
Audreann Nelson | Texas Christian University
*Cecily Northcut | Laguna College of Art and Design
Jack Nurenburg | Boston University
Dylan Oddy | University of Idaho
Liam Pham | New York University
Tom Qiu | Yale University
Caroline Ragan | Gettysburg College
Cooper Raney | University of Arizona
Camila Rivera | Southern Methodist University
Christian Rockamore | University of Oregon
Andrew Santone | Syracuse University
Elizabeth Sawers | New York University
Blake Scheinberg | Texas A&M University
Layne Scheinberg | Texas A&M University
Rohan Schlehuber | Indiana University Bloomington
Will Searcy | The University of Texas at Austin
Elisabeth Siegel | Barnard College
Amelia Sinwell | Washington & Lee University
Ella Sjogren | Wake Forest University
Sevy Smith | University of North Texas
Teddy Sparrow | Washington & Lee University
Ashley Stacy | University of Richmond
*Sydney Stuelpe | Southern Methodist University
Daniel Sucato | Rochester Institute of Technology
Jake Swift | University of Texas at Austin
Lily Tollison | Radford University
Sally Tomlin | Texas Christian University
*Sophia Ukeni | Cornell University
Eleanor Vig | University of Mississippi
Bridget Wang | University of Southern California
Alexandra Warner | University of Michigan
Grace Williams | The University of Sydney
Grace Worsham | Davidson College
*not pictured